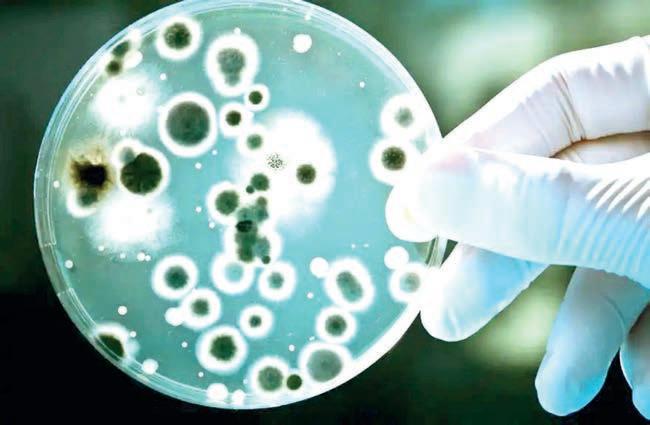

REALIZAN
CIRUGÍA EXITOSA
IMSS Bienestar-Veracruz retira tumor mamario a niña de 12 años en el HAEV.

![]()

IMSS Bienestar-Veracruz retira tumor mamario a niña de 12 años en el HAEV.

Instalan nuevos corrales de inspección en la frontera sur, para mayor detección del GBG.


Contempla
SU ADEUDO HISTÓRICO
También redujo de 25 mil a 11 mil millones el saldo con el ISSSTE. Hay disciplina financiera sin frenar obra ni servicios.

En Michoacán, el 24 de noviembre inician las asambleas informativas; es un apoyo para transporte público.
Congreso eleva a rango constitucional la protección a los animales.


PROPONEN REFORMAR DISPOSICIONES DEL ARTÍCULO 22
Reestructurarían facultades administrativas del Tribunal de Conciliación y Arbitraje.
En Michoacán, el 24 de noviembre inician las asambleas informativas; es un apoyo para transporte público
AGENCIAS
CIUDAD DE MÉXICO
El Gobierno de México, a través la Secretaría de Educación Pública (SEP), informó que, como parte del Plan Michoacán para la Paz y la Justicia, a partir del lunes 24 de noviembre inician en 121 escuelas las asambleas informativas de la beca Gertrudis
Bocanegra, que consiste en un apoyo para transporte público de mil 900 pesos bimestrales, en atención a una matrícula de 98 mil 569 con una inversión de 769 millones de pesos (mdp).
El secretario de Educación Pública, Mario Delgado Carrillo, puntualizó que en Educación Básica se han invertido 4 mil 977 millones de pesos, con la entrega de 5.59 millones de becas Universal Rita Cetina y la intervención de 16 mil 297 secundarias con La Escuela Es Nuestra (LEEN). En Educación Media Superior, detalló, se ha realizado una inversión de 4 mil 429 mdp con la entrega de 4 millones de becas Universal Benito Juárez y la intervención de 6 mil 50 bachilleratos con la LEEN.
Destacó que en la creación de nuevos lugares para Educación Media Superior se tiene un avance del 85 por ciento respecto a la meta de 120 mil lugares nuevos, lo que representa 44 mil 685. Recordó que en 2026 se crearán 65 mil 400 lugares con 20 bachilleratos tecnológicos, 52 ampliaciones y 130 mil bachilleratos que queden cerca de la casa, además son 30 mil lugares del Plan Michoacán, con ello, se estaría superando la meta planteada para todo el sexenio. En el caso de la Educación Superior, la meta es la creación de 330 mil lugares, para ello las instituciones deberán incrementar en 17 por ciento su matrícula, con lo

que se tendría un 55 por ciento de cobertura.
La directora general del Programa LEEN, Pamela López Ruiz, destacó que este 2025 se han beneficiado 69 mil 302 escuelas: 63 mil 252 de Educación Básica y 6 mil 50 de Educación Media Superior a través de una inversión de 25 mil mdp en beneficio de 8.1 millones de estudiantes. Informó que, durante noviembre se realiza la entrega de medios de pago a 5 mil 25 Comités, mientras que en diciembre se realizará el pago a las escuelas de Puebla y Veracruz, con la dispersión mil 942 mdp.
El coordinador nacional de Becas para el Bienestar, Julio César León Trujillo, destacó que las Becas para el Bienestar benefician a más de 13 millones de estudiantes de los tres niveles educativos por medio de una inversión de 73 mil mdp. Detalló que con la beca Universal Rita Cetina se han beneficiado a 8.8 millones de estudiantes, con una inversión de 42.6 mil mdp; de la beca Universal Benito Juárez se apoya a más de 4 millones de estudiantes con una inversión de 23.6 mil mdp; de Jóvenes Escribiendo el Futuro, 409 mil 266 beneficiados con una inver-


sión de 7.6 mil mdp.
INICIA PAGO A NUEVAS
BENEFICIARIAS DE LA PENSIÓNMUJERESBIENESTAR
El Gobierno de México, a través de la Secretaría de Bienestar, informó que, del 18 al 21 de noviembre, las mexicanas de entre 60 y 64 años que se registraron en agosto a la Pensión Mujeres Bienestar y recibieron su tarjeta en octubre, se les otorgará su primer pago de este apoyo de 3 mil pesos bimestrales.
En la conferencia matutina: “Las mañaneras del pueblo”, que encabeza la Presidenta de México, Claudia Sheinbaum Pardo, la secretaria de Bienestar,
Ariadna Montiel Reyes, detalló que el depósito se realizará de acuerdo con la letra del primer apellido bajo el siguiente calendario:
Martes 18 de noviembre - A, B, C, D; Miércoles 19 de noviembre - E, F, G, H, I, J, K; Jueves 20 de noviembre - L, M, N, Ñ, O, P, Q y Viernes 21 de noviembre - R, S, T, U, V, W, X, Y, Z. Además, la fecha de pago se puede consultar en la página oficial de la Secretaría de Bienestar: gob.mx/bienestar. Agregó que, a la fecha, casi 3 millones de mujeres de 60 a 64 años son beneficiarias de la Pensión Mujeres Bienestar.
Resaltó que los Programas
para el Bienestar llegan a un número histórico de 18 millones 494 mil 201 beneficiarios mediante una inversión social de 99 mil 183.7 millones de pesos (mdp): 13 millones 232 mil 13 son derechohabientes de la Pensión para el Bienestar de las Personas Adultas Mayores; 1 millón 614 mil 18 de la Pensión para el Bienestar de las Personas con Discapacidad; 256 mil 301 del Programa para Madres Trabajadoras; y 409 mil 647 de Sembrando Vida. El secretario del Trabajo y Previsión Social, Marath Bolaños López, agregó que, al día de hoy, son 3 millones 423 mil 461 beneficiarios del programa Jóvenes Construyendo el Futuro, lo que significa una inversión de 158 mil mdp, mientras que tan solo en el Segundo Piso de la Cuarta Transformación son 450 mil, con una inversión estimada al 28 de noviembre de más 21 mil mdp y se estima que sea de 24 mil 205 mdp al 31 de octubre.
Añadió que la próxima fecha de inscripciones a Jóvenes Construyendo el Futuro es el 1 de diciembre de 2025 y se espera dar una atención a 500 mil personas.
Director General
Director General Lic. Francisco Sánchez Macías
Dr. Rubén Pabello Rojas Gerente Administrativo L.A.E. María del Socorro López Lagunes
Director Corporativo
Ing. Eduardo Sánchez Macías
Directora Editorial
Lic. Julia Méndez Campos
Director Editorial
Lic. Rafael Meléndez Terán
Comercial Lic. José de Jesús López Hernández
Jefe de Redacción
Lic. Misael Leyva Julio Jefe de Información
de Redacción Lic. Ivonne Méndez
Lic. Teresa de Jesús Blasco Ramírez
de Publicidad
Jefe de Diseño y Producción
LCC Rafael Melgarejo Escudero
Óscar Rojas Barradas
El Heraldo de Xalapa es una publicación de lunes a sábado. Editor responsable Ing. Eduardo Sánchez Macías. Número de Certificado de Reserva de Derecho al Uso Exclusivo del título 04-2010052510203900-101. Certificado de Licitud de Título: 15357. Certificado de licitud de contenido 15357. Domicilio de la publicación, impreso y distribuido por El Heraldo de Xalapa, con domicilio en Av. Ávila Camacho No. 10 Altos, Col. Centro, C.P. 91000, Xalapa, Ver. TEL. 01 (228) 0409552, 8419319, 8419363 y 8419437.
A través de una Iniciativa de Decreto, el diputado Juan Tress Zilli propuso reformar diversas disposiciones del Artículo 22 Ter de la Ley Orgánica del Poder Ejecutivo, de la Ley Estatal del Servicio Civil y del Artículo 33 de la Ley Orgánica del Poder Judicial, todas del Estado de Veracruz, con la finalidad de aminorar la carga administrativa y responsabilidades del Tribunal de Conciliación y Arbitraje de Veracruz (TCA), a fin de garantizar una impartición de justicia pronta y expedita.
Actualmente, explicó el legislador, como parte de las atribuciones del TCA, está la solución de conflictos laborales entre trabajadores y entidades públicas estatales o municipales, los individuales que se susciten con servidores públicos, los conflictos colectivos laborales, así como los internos de los sindicatos.
Puntualizó que el citado Tribunal es el encargado de lle-
Martes 18 de

var a cabo el registro y gestión de todos los conflictos. “Todas estas actividades, generan una sobrecarga de responsabilidades dificultando su capacidad para atender de manera expe-
»AGENCIAS
XALAPA.- Por unanimidad, el Pleno de la LXVII Legislatura de Veracruz aprobó el dictamen por el cual se consagra en la Constitución Política del Estado el reconocimiento explícito de los animales como seres sintientes y, en consecuencia, como sujetos de una especial protección jurídica.
El dictamen, resultado de la iniciativa presentada el pasado 25 de abril por el Grupo Legislativo del Partido Verde Ecologista de México (PVEM) y leída en tribuna por la diputada Nallely Mendoza Camarillo, expone que se busca superar la concepción del animal como un simple objeto o recurso, para elevarlo a una categoría que exige un trato digno y respetuoso, en armonía con la evolución del derecho contemporáneo.
De esta manera, se incorpora en el Artículo 8 de la Carta Magna que la Constitución y las leyes del Estado reconocen a los animales como seres sintientes sujetos de una especial protección, para garantizar su bienestar integral a través de un trato digno y respetuoso, y así procurar las bases para una convivencia armónica entre el ser humano y el resto de las especies.
En el Estado toda persona tiene el deber ético y la obligación jurídica de respetar la vida y la integridad de los animales. Las leyes determinarán las medidas de protección de los animales, incluida la atención a aquellos en situación de maltrato, crueldad o abandono.
Además, establecerán las bases para regular el trato hacia los animales en todas las actividades humanas, asegurando su bienestar conforme a su naturaleza, así como la implementación de programas de educación y concientización sobre una tutela respon-
dita y eficiente los conflictos laborales como órgano jurisdiccional especializado”. Ante esto, planteó una reestructuración a la normativa a fin de trasladar dichas funcio-

sable. Se incluye en el Artículo 10 que los programas educativos deberán incluir la promoción del respeto, la tutela responsable, el trato digno y la protección de los animales como parte de una educación ambiental, ética y cívica integral. En cuanto al Artículo 33 se faculta a este Congreso para legislar en materia de protección, bienestar y de trato digno y respetuoso a los animales.
En relación con el Artículo 71 se establece que los Ayuntamientos deberán establecer políticas, reglamentos y programas para la especial protección y bienestar de los animales, garantizando su trato digno y respetuoso, así como promover la educación y cultura de respeto hacia todas las especies, en coordinación con las autoridades competentes del Estado y la Federación. En las disposiciones transitorias, se prevé que los municipios cuenten con un plazo de 180 días para actualizar su normatividad interna, bandos de policía y buen gobierno, reglamentos, y para la capacitación de su personal, garantizando la correcta aplicación de la presente reforma. La presidenta de la Mesa Directiva, diputada Naomi Edith Gómez Santos, instruyó la apertura del sistema electrónico de votación, lo cual dio como resultado 38 votos a favor, sin abstenciones o votos en contra.
nes administrativas de registro sindicales y condiciones generales de trabajo, a la Secretaría de Trabajo, Previsión Social y Productividad de Veracruz (STPS), con lo cual, el TCA podrá
Impulso al turismo regional a través de los Consejos Consultivos, convoca diputado
»AGENCIAS
XALAPA.- A través de un Anteproyecto de Punto de Acuerdo, el diputado Rafael Gustavo Fararoni Magaña hizo un llamado a la Secretaría de Turismo del Estado de Veracruz (Sectur) y a las autoridades electas de los municipios con vocación turística a convocar y poner en funcionamiento los Consejos Consultivos Regionales de Turismo, correspondientes a las demarcaciones reconocidas en la Ley de Turismo de Veracruz, así como dar seguimiento para su respectiva evaluación de resultados en el corto y mediano plazo.
En la tribuna, el diputado indicó que, de acuerdo con la Ley Estatal de Turismo de Veracruz, la entidad cuenta con siete Regiones Turísticas: Huasteca; Totonaca;
dedicar sus recursos humanos y materiales a sus funciones de resolución de conflictos colectivos, huelgas y controversias individuales.
“Este enfoque optimizará su operatividad y mejorará la calidad de las resoluciones judiciales, respondiendo a los principios de eficiencia administrativa, especialización y congruencia con el marco legal nacional e internacional en materia laboral, garantizando la democracia sindical”, concluyó.
A la iniciativa se adhirió el Grupo Legislativo de Morena y fue turnada a las Comisiones Permanentes Unidas de Justicia y Puntos Constitucionales, de Gobernación, y de Trabajo y Previsión Social, para su estudio y dictamen.
Cultura y Aventura; Primeros Pasos de Cortés, Altas Montañas; Los Tuxtlas y Olmeca. Dijo que para lograr el éxito en materia de turismo se requiere del esfuerzo conjunto entre autoridades, prestadores de servicios e inversionistas, así como de recursos oficiales para su impulso y promoción, “por lo que la creación oportuna de los Consejos Regionales de Turismo permitirá que desde sus primeros meses de gestión puedan coordinarse con sus pares y trabajar de manera armónica entre regiones”.
El integrante de Morena recordó que, de acuerdo con la normativa, dichos consejos permiten que los municipios avecindados en una región se organicen, promuevan e inviertan, coordinadamente, focalizando esfuerzos y recursos.
Además, prevé que gobiernos municipales y sector privado, participen y planteen propuestas apegadas a las características de cada región, respetando usos y costumbres de pueblos originarios y afromexicanos y su inclusión en planes y programas de trabajo. “El impulso y adecuado funcionamiento de los Consejos Consultivos Regionales de Turismo, dependerá en gran parte de la Sectur y las administraciones municipales que forman cada Región, su convocatoria y coordinación con la iniciativa privada debe ser constante para que haya resultados en plazos más cortos, así como la continuidad de proyectos o atracciones”, concluyó el diputado.

Primera Sección
18
También redujo de 25 mil a 11 mil millones el saldo con el ISSSTE. Hay disciplina financiera sin frenar obra ni servicios
»AGENCIAS
XALAPA.- La gobernadora Rocío Nahle García informó que Veracruz logró reducir en un 42 % la deuda total del Estado durante el primer año de su administración, al pasar de 119 mil millones a 62 mil millones de pesos, todo ello sin detener la inversión en obra pública, seguridad, salud ni programas sociales. La reducción se alcanzó gracias a una estrategia financiera que permitió liquidar al 100 % el adeudo histórico con la autoridad fiscal, al cubrir totalmente los 30 mil millones de pesos acumulados desde 2009.
Destacó que Veracruz es el único estado que se acogió y cumplió en su totalidad con el programa federal Deudor Cumplido, “hoy la deuda con el SAT está en cero, después de 16 años; aprovechamos una oportunidad única y lo hicimos por el bien de Veracruz”.
Como parte de los acuerdos con la Federación, el Estado también redujo de 25 mil a 11 mil millones de pesos su adeudo ante el ISSSTE; y se sigue trabajando con el Gobierno de México para garantizar los recursos correspondientes a las cuentas indi-

viduales de las y los trabajadores. Nahle subrayó que esta disciplina financiera se aplicó sin sacrificar la inversión estratégica, destacando la adquisición de patrullas, uniformes y el incremento salarial para
policías; la compra de Camionetitas de la Salud y el fortalecimiento de programas sociales. Además, la creación del Fideicomiso público, irrevocable, de administración, inversión y pagos

Instituciones educativas que habían sido afectadas por lluvias en zona de la Huasteca, recibieron apoyo de la SEV
AGENCIAS
HUAYACOCOTLA
En el albergue comunitario de Huayacocotla, decenas de alumnos de Xaltipa, comunidad indígena náhuatl perteneciente al municipio de Ilamatlán, recibieron mobiliario para preescolar y primaria de parte del Gobierno del Estado, a través de la Secretaría de
Educación de Veracruz (SEV), consistente en pupitres y pintarrones, además de material didáctico.
Cabe recordar que la comunidad de Xaltipa, Ilamatlán, y aulas escolares resultaron afectadas severamente por piedras y lodo arrastrados con el agua, por lo que se encuentran en un albergue temporal en la cabecera municipal de Huayacocotla.
Miguel Cruz Hernández, jefe del sector 03 de educación indígena en la región de Huayacocotla, informó que, en la reunión con los padres de familia, autoridades de la localidad, y personal docente, se buscaron los espacios para que los alumnos puedan reiniciar sus actividades escolares.
En coordinación con la dirección de la escuela primaria Wilfrido García, se plantearon necesidades urgentes como son aulas móviles, mobiliario, pintarrones, uniformes, útiles y mochilas escolares, mismas que se seguirán atendiendo.
para la modernización del transporte público de pasajeros; la inversión en la tecnificación del campo, con tractores, semillas y acciones de siembra así como la atención prioritaria a la región norte tras la reciente
Instalan nuevos corrales de inspección en la frontera sur, para mayor detección del GBG
AGENCIAS
XALAPA
Para fortalecer la trazabilidad y la salud del ganado, la Secretaría de Agricultura y Desarrollo Rural (Agricultura), a través del Servicio Nacional de Sanidad, Inocuidad y Calidad Agroalimentaria (Senasica), ha puesto en marcha los corrales habilitados para la aplicación de medidas zoosanitarias integrales en la frontera sur como parte de los protocolos implementados entre el Gobierno de México y Estados Unidos.

contingencia.
La Gobernadora explicó que estos avances forman parte del Informe entregado el 15 de noviembre a la LXVII Legislatura y precisó que ampliará dichos resultados ante la ciudadanía el próximo domingo 30 de noviembre en Plaza Lerdo, a donde invitó a las y los veracruzanos para conocer de manera directa los logros del primer año de su gestión.
Se han autorizado puntos de verificación e inspección ganadera en diversas zonas, incluyendo el sur de Veracruz (Acayucan, Playa Vicente, Catemaco, entre otros) y Chiapas, con planes de expansión a otros estados para cubrir rutas clave de movilización.
Esta estrategia integral tiene como objetivo principal fortalecer la trazabilidad y la salud del ganado, especialmente el proveniente del sur del país, y mitigar riesgos sanitarios, como la propagación del Gusano Barrenador del Ganado (GBG). En estos corrales, médicos veterinarios autorizados por el Organismo Internacional Regional de Sanidad Agropecuaria (Oirsa) y Senasica realizan inspecciones físicas del ganado, aplican tratamientos larvicidas y llevan a cabo otras medidas sanitarias necesarias; posteriormente, colocar el arete sanitario y emitir el Certificado Zoosanitario de Movilización (CZM); estas acciones buscan mejorar el estatus sanitario de las regiones ganaderas, permitiendo a los productores acceder a más y mejores mercados nacionales e internacionales.


IMSS BienestarVeracruz retira tumor
mamario a niña de 12 años en el HAEV
AGENCIAS VERACRUZ
En el Hospital de Alta Especialidad IMSS Bienestar de Veracruz se realizó con éxito una cirugía compleja a una paciente de 12 años para extirpar un tumor mamario de gran tamaño, el cual, en el caso de no brindar atención, era condicionante a generar cáncer de mama.
Fue el cirujano pediatra Guillermo Martínez Oropeza, adscrito al Hospital de Alta Especialidad IMSS Bienestar de la ciudad de Veracruz, quien detalló el procedimiento qui-

rúrgico que se le realizó a la niña María “N” a través de un video que publicó la institución en sus redes sociales.
“Es una paciente de 12 años, realizamos una mastectomía simple, esto debido a que era un tumor que, al parecer por las biopsias que le tomaron, determinaron que era una patología benigna, pero se comportaba como una patología maligna
debido a que estaba enorme”, agregó.
Martínez Oropeza dijo que este tipo de casos resultan raros, ya que se trató de una niña de 12 años con un tumor tan grande. El cirujano pediatra destacó que se trató de un logro del Hospital de Alta Especialidad IMSS Bienestar de Veracruz.
“Me siento muy contento, me siento feliz, le doy gracias al

Los trabajos se verán fortalecidos gracias a la donación de asfalto por parte de Pemex
»AGENCIAS
VERACRUZ.- La gobernadora de Veracruz, Rocío Nahle, confirmó que su administración trabajará de manera coordinada con la próxima alcaldesa de Veracruz, Rosa María Hernández Espejo, para impulsar un amplio programa de pavimentación en colonias, especialmente en zonas periféricas del municipio.
Nahle García destacó que la nueva presidenta municipal ya presentó un listado de obras prioritarias para la ciudad.
“Ya me pidió toda una lista de lo que tenemos que hacer para pavimentar muchísimas calles en Veracruz, sobre todo de las colonias
de la periferia. Sí, la voy a ayudar”, aseguró. La mandataria indicó que el propósito es atender rezagos históricos en infraestructura urbana y mejorar la movilidad en zonas con mayor necesidad.
Nahle explicó que los trabajos se verán fortalecidos gracias a la donación de asfalto por parte de Pemex, institución que apoya a los municipios donde mantiene operaciones.
“Pemex nos donó asfalto para ciertos municipios y Veracruz entra dentro de esos municipios… Pemex dona asfalto para municipios donde él tiene operaciones y Veracruz entra para esto”, detalló.
Este material permitirá iniciar obras de pavimentación en diversas colonias sin retrasos y con recursos asegurados.
La gobernadora subrayó que el programa no se limitará a colocar nuevas capas de asfalto, sino que incluirá infraestructura básica para evitar problemas futuros.
“No nada más para pavimentar, tenemos que hacer el sistema de drenaje”, afirmó.
Explicó que las recientes afectaciones en otros municipios del estado evidenciaron la importancia de atender de manera simultánea drenajes obsoletos o colapsados para garantizar la durabilidad de las obras.

equipo de trabajo y al hospital”, insistió. Por su parte, María “N” contó que no deseaba que le realizaran la cirugía porque implicaba que le retiraran el pecho.
Sin embargo, la niña aceptó que se le realizara el procedimiento quirúrgico porque sería por su bien.
“La verdad es que el Hospital
Casi 400 personas acuden a realizarse la detección de cáncer de próstata en Veracruz, 17 pacientes requieren una segunda revisión
AGENCIAS VERACRUZ
La doctora Ana María Autrán Gómez, directora de Urolatam y miembro del comité ejecutivo de la Confederación Americana de Urología, señaló que en la cuarta Jornada de detección y prevención de cáncer de próstata en la Facultad de Medicina de la Universidad Veracruzana (UV) atendieron a 370 personas.
Detalló que de la cifra de personas que atendieron, 17 pacientes requieren una
de Alta Especialidad IMSS Bienestar Veracruz está dando todo lo que tiene y estamos sacando pacientes muy complejos, la verdad es excelente poder dar de alta a un paciente tan complejo, un resultado positivo y contar con el apoyo de una gran institución”, finalizó Guillermo Martínez Oropeza.
segunda revisión con otros exámenes para descartar un problema.
“Sí 17 pacientes sí presentan requerimos una segunda revisión, es decir, requerimos de estudios de imagen para poder evaluar los resultados que se obtuvieron tanto clínicos como de antígeno prostático”.
Añadió que no se registra un incremento en los casos de pacientes que detectaron que requieren una revisión más exhaustiva para descartar cáncer, en comparación con otros años.
“Hemos mantenido en el 15, el 14 % en las jornadas anteriores entonces podemos decir que estamos más o menos sobre el mismo el mismo porcentaje”, expresó.
Aseveró que, a diferencia de otros años, está vez el 42 % de las pacientes que acudieron a la jornada son personas que no cuentan con una asistencia social, en el 2022 cuando inició el programa eran solo 23%.

Los líderes del PAN y el PRI saben que no pueden aglutinar mucha gente si convocan a una marcha con sus colores y en nombre de sus partidos, así que, desde hace algunos años, buscan cómo nombrar a esa masa dispersa que los sigue, a pesar de todos.
Antes fue la Marea Rosa, luego la sociedad civil, ahora es la generación Z, pero en esencia siguen siendo los mismos y así lo confirman los asistentes a la marcha cuyo protagonismo les impulsa aparecer ante los reflectores de los medios.
Ahí estuvieron Guadalupe Acosta Naranjo, Emilio Álvarez Icaza, Vicente Fox, Fernando Belauzarán, Rafael Loret de Mola, conductores de noticias de TV Azteca, y otros identificados con partidos políticos.
La transmisión del Grupo Azteca, que de ahora en adelante se llamará, para evadir más impuestos, Operadora Mexicana de Televisión, empezó a denunciar represión de la policía cuando todavía no llegaban los contingentes al zócalo. Es decir, la mentira se adelantó y mostró su falsedad.
Lo sucedido en la marcha pareciera

FRACASA LA MARCHA DE LA DERECHA
convertirse en un hecho diferente al que narran los medios, los cuales reiteran que hubo represión.
El saldo fue de 100 policías agredidos, 60 de ellos atendidos en el lugar, mientras que 40 fueron trasladados a un nosocomio. Además, se atendió 20 civiles por diferentes lesiones.
Tanto el secretario de Seguridad como el de Gobierno, reconocieron la actuación de los uniformados, quienes únicamente intervinieron cuando comenzaron los hechos violentos.
La generación Z sirvió de pretexto para sustituir fracasos anteriores, aunque éste fue el mayor de todos, porque cada vez asiste menos gente a las convocatorias de la derecha, a pesar de los incidentes recientes ocurridos en Uruapan, cuando consideraron podría incluso derrocar a Morena y tumbar a la presidenta Claudia Sheinbaum.
Los medios realizan dos tareas paralelas e intensas, primero afirmar que hubo represión y segundo, legitimar a la Generación Z como un movimiento social nutrido y de jóvenes, lo cual es mentira.
La marcha que se anunció multitu-

Hay que decirlo sin rodeos: cuando casi todo se tambalea entre discursos huecos y promesas recicladas, aún existen espacios donde la vida cotidiana conserva un orden propio, más honesto y más antiguo que cualquier decreto oficial. Uno de esos respiros —tan necesarios como subestimados— es el tianguis. Ese invento prehispánico que, pese a las modernizaciones caprichosas y los funcionarios que suelen legislar sin conocer la calle, sobrevive con la obstinación de quien sabe que su raíz es más profunda que la memoria institucional. Este domingo caminé —como tantas veces— el tianguis de la calle Toluca. No fui por nostalgia ni por romanticismo urbano: fui a constatar que todavía se puede mirar de frente una forma de economía más humana que la de los centros comerciales blindados por el crédito (EL BUEN FIN). Allí, entre los puestos alineados a pulso, la realidad se organiza con una eficiencia que muchos gobiernos envidiarían: el regateo civilizado, la transacción directa, la confian-
dinaria no llegó ni a los 15 mil asistentes. Se dijo sería pacífica e hicieron destrozos, su propósito era obligar a la población a pensar que la inseguridad sigue siendo el problema principal de México.
El líder nacional del PRI, Alejandro “Alito” Moreno se pronunció en sus redes sociales diciendo que “el cobarde narcogobierno de Morena, se esconde tras las vallas de la soberbia y lanza gases contra las juventudes que luchan por un México con rumbo”. Pero el sempiterno líder del PRI no asistió a la marcha.
Ese sábado la derecha marcho tratando de esconder bajo el disfraz de la violencia su verdadero rostro, más agresiva, y desafiante, portando imágenes guadalupanas y banderines blancos, aparentemente pacífica pero cargada de petardos, cohetones, pedradas y bombas de humo, herramientas para tumbar las vallas, gas pimienta, etc.
Mientras los manifestantes gritaban queremos paz realizaban destrozos en lo que encontraban a su paso.
Los sombreros, al estilo Carlos Manzo se vendían a 150 pesos en un tendido a media plancha del zócalo, pero no era necesario, porque colaboradores del
za que no necesita firma digital.
Pero lo mejor de todo quizás, la degustación de exquisitos manjares de la culinaria veracruzana, gorditas, picadas, tapadas de frijol, tamales de todo tipo, quesos, frutas, legumbres recién cortadas.
Los tianguis, desde el tianquiztli mexica hasta los de hoy, han sido algo más que un espacio de compraventa. Fueron centros de vida social, lugares donde se intercambiaban no solo productos, sino información, acuerdos, alianzas. En ellos se definía parte del ritmo político y comunitario. A diferencia del mercado moderno, que vende la ilusión de la abundancia empaquetada, el tianguis mantiene el pulso vivo del territorio, aunque algunos pretendan verlo como folclor para turistas o estorbo para la movilidad.
Lo que encontré este domingo no fue la postal para redes sociales: fue la contundente demostración de que la economía popular mantiene al país en marcha sin pedir aplausos ni subsidios.
Verduras frescas a precios que cualquier familia puede pagar; frutas que aún huelen a fruta, no a refrigerador industrial; rostros que trabajan desde antes del amanecer para sostener un ingreso que los informes oficiales rara vez reconocen.
Ahora bien, también es cierto que esta tradición enfrenta amenazas silenciosas: proyectos de “reordenamiento” que muchas veces significan expulsión; reglamentos que se aplican con mano dura solo a quienes carecen de padrinos políticos; campañas que criminalizan al comerciante ambulante mientras toleran monopolios más agresivos. La desigualdad también se vende, y siempre a sobreprecio.
Lo que el tianguis de la calle Toluca nos recuerda —con la elocuencia de lo simple— es que la cultura no se preserva con discursos, sino con prácticas vivas. No basta presumir raíces indígenas mientras se desalojan espacios que representan continuidad histórica. No basta hablar de apoyo a la economía fa-
partido Somos MX, los regalaban al que lo solicitara.
Grupos bien organizados de encapuchados realizaron ataques a las vallas del Palacio Nacional. Con martillos, esmeriles y marros rompían adoquines para lanzarlos sobre y contra las vallas. Los pocos asistentes de la auténtica Generación Z, se vio rebasada en número por sus mayores, muy mayores pero padres, abuelos y tíos les dedicaron la marcha como para darles ánimos.
Más de una coincidencia mostraba al verdadero organizador de este evento que más parecía un montaje que una protesta social. Los asistentes elogiaban al presidente de El Salvador, Nayib Bukele, con quien el evasor fiscal, Ricardo Salinas Pliego se había reunido semanas antes.
El delincuente común llamado Ricardo Salinas prefiere incendiar el país antes que pagar lo que le debe al SAT. Se ha dedicado a movilizar a los productores de maíz.
miliar si se impulsa una modernización que excluye precisamente a quienes sostienen esa economía. Por eso conviene mirar el tianguis no como una reliquia, sino como una lección de organización social, resistencia económica y dignidad cotidiana. Tal vez sea hora de que nuestras autoridades —tan afectas a inaugurar obras vistosas— visiten un domingo cualquiera un tianguis y aprendan cómo se gestiona un espacio público sin perder el respeto por la comunidad.
Porque, al final, en esos puestos improvisados se vende algo más que productos frescos: se vende la prueba de que este país todavía tiene pulso propio. Y eso, créamelo, no tiene precio.
Martes 18 de
El Heraldo de Xalapa
Martes 18 de Noviembre de 2025


AGENCIAS
MÉXICO
El próximo Desfile Cívico-Militar del 20 de noviembre estará integrado por un contingente de más de 3 mil militares y civiles, y destacará el papel de la mujer en la Revolución Mexicana. Además, se incluirá un capítulo especial para los deportistas militares, como beisbolistas y medallistas olímpicos.
El ensayo se realizó este lunes y fue encabezado por el general Ricardo Trevilla, secretario de la Defensa Nacional.
Tribunal garantiza independencia judicial
AGENCIAS
CIUDAD DE MÉXICO
El Tribunal de Disciplina Judicial (TDJ) tiene pleno respeto a la independencia judicial, por ello, los impartidores de justicia deben estar tranquilos y confiar en que sus decisiones jurisdiccionales no serán objeto de sanción, pues este órgano sólo actuará cuando incurran en faltas administrativas y malas conductas, manifestaron la presidenta de este órgano, Celia Maya García y el magistrado Rufino H León Tovar.
El TDJ informó que al participar en la “52 Convención Anual de la Asociación Nacional de Abogados de Empresas (ANADE) 2025,” que se lleva a cabo en Puebla, señalaron que el objetivo principal del órgano jurisdiccional es abatir la corrupción que pudiera estar presente en los tribunales, además de acabar con el rezago en los asuntos pendientes, y erradicar la impunidad y devolver la confianza ciudadana al Poder Judicial (PJ). Ahí la magistrada Maya García comen-
El pase de revista se realizó en la explanada “Damián Carmona” del Campo Militar Número 1, en la Ciudad de México, y duró poco más de una hora y media. Fue más breve que lo programado para el próximo jueves en el Zócalo capitalino, ya que se omitieron los discursos de la presidenta y del general secretario, así como el vuelo de aeronaves y otras actividades que sí se llevarán a cabo ese día. Durante el ensayo por el 115 aniversario del inicio de la Revolución Mexicana desfilaron una Bandera monumental, cuatro estandartes de guerra, 2 mil 839 integrantes del Ejército Mexicano y
Fuerza Aérea, 28 deportistas, 100 charros, 44 civiles y 62 niños, 34 vehículos terrestres, 20 vehículos antiguos, 23 aeronaves, 499 caballos y tres aves. El desfile ante el pueblo mexicano revivirá tres pasajes de la Revolución: el Plan de San Luis, la Marcha de la Lealtad y la Promulgación de la Constitución de 1917. Además de las representaciones teatrales, se preparan carros alegóricos con figuras de cada personaje: tráilers con grandes sombreros, lentes y rostros de figuras históricas como Porfirio Díaz — cuyo periodo de dictadura será recreado— y Francisco I. Madero, el llamado

tó que la idea que impulsó la reciente reforma judicial es que toda persona que acuda ante los órganos de justicia confíe en ellos, “que la ciudadanía sepa que tiene un Poder Judicial totalmente confiable, independiente, que va a dar sus resoluciones sin ninguna presión”. Aseguró que las garantías de la función jurisdiccional son intocables y sólo se espera que los jueces no se aparten de la ley y que sus decisiones sean apegadas a derecho.
“El Tribunal lo único que tendrá que hacer es observar si esta conducta de los jueces realmente se ajustó a la ley”. A la ciudadanía en general y abogados presentes en la convención de la ANADE les pidió tener confianza en el TDJ, porque
sus integrantes tienen la mejor de las intenciones y trabajan con ahínco para conformar un nuevo y mejor PJ y, “sobre todo, porque vamos a velar por la independencia de los jueces”.
Al respecto, el magistrado León Tovar, afirmó que el TDJ es un órgano de estricta legalidad, que “no obedece a intereses de nadie, ni de partidos, ni de poderes, ni de grupos políticos”, en el cual sus integrantes están plenamente convencidos de que por encima de la ley nada.
Detalló que entre las funciones principales del TDJ se encuentran ser garante de la conducta correcta de todos los juzgadores del país en la impartición de justicia y también en la interacción que
“apóstol de la democracia”. Pero también se preparan carrozas dedicadas a mujeres que “marcaron la historia del país” y destacaron durante la Revolución, como Adela Velarde Pérez; Refugio Esteves Reyes, “madre Cuca”, primera enfermera militar; la escritora y activista Hermila Galindo Acosta; Emma Catalina Encinas Aguayo, primera mujer piloto aviador; así como el contingente Rosa Padilla Camacho.
También participarán contingentes dedicados a Felipe Ángeles, “militar y humanista mexicano”, y a Francisco J. Múgica.
tienen, tanto con el personal a su cargo, como con los justiciables; realizar la evaluación de la carrera judicial de todas las personas juzgadoras del país, y dirimir las controversias que se susciten entre el PJ y sus trabajadores.
Agregó que el TDJ tiene facultades para iniciar investigaciones, procedimientos y aplicar sanciones a aquellos juzgadores cuya conducta se aparte de la ley, pero siempre apegado al cumplimiento del debido proceso, observando las garantías legales y constitucionales que deben las implicadas. “Todos los juzgadores del país deben tener la certeza de que el Tribunal no debe trastocar, ni lo va a hacer, la autonomía jurisdiccional. Si lo hiciéramos, la justicia en el país no tendría sentido”.


El objetivo es brindar un momento de convivencia y diversión a todas las niñas y niños de la región
»IRIS ROMÁN
TUXPAN.- Luego de varios años sin realizarse, el Desfile por el Día del Payaso volverá este año al municipio de Tuxpan, con el objetivo de brindar un momento de convivencia y diversión a todas las niñas y niños de la región. En entrevista, el payaso Irineo Cruz, conocido como “Campanita”, informó que el evento se llevará a cabo el miércoles 10 de diciembre a partir de las 3:00 de la tarde. El punto de reunión será AutoZone, desde donde iniciará el recorrido por todo el boulevard, continuando por las calles Genaro Rodríguez y Avenida Juárez, para finalizar en la Plaza Cívica.
Al término del desfile, a partir de
las 4:00 de la tarde, se realizará un espectáculo especial para el público infantil en la Plaza Cívica, donde se ofrecerán dinámicas, regalos y sorpresas. Se prevé la participación de alrededor de 40 payasos provenientes de Tuxpan y de otros estados, así como de municipios vecinos como Álamo, Papantla, Poza Rica y Naranjos.
Los organizadores extendieron una invitación abierta a niñas y niños que deseen incorporarse al desfile caracterizados de superhéroes, princesas o cualquier personaje infantil. Familias, patrocinadores y comparsas también podrán participar.
De acuerdo con Campanita, el evento cuenta con el apoyo de Tránsito Municipal, Protección Civil y Policía Municipal, con el fin de garantizar el orden durante el recorrido. Destacó que la fecha coincide con la celebración del Día del Payaso, que se conmemora cada 10 de diciembre a nivel nacional.
Los organizadores coincidieron en que esta edición representa una oportunidad para devolverle alegría a los niños luego de varios años sin esta tradición. “Queremos que los pequeños se diviertan y recordarles que la sonrisa es lo mejor que hay en la vida”, expresaron.
Piden reconsiderar plan de Turismo previsto para 2026, al señalar que afectaría la promoción turística del estado
AGENCIAS
XALAPA.- Empresarios hoteleros de la región solicitaron reconsiderar la disminución prevista para la Secretaría de Turismo en el proyecto de presupuesto 2026 enviado por la Secretaría de Finanzas y Planeación (Sefiplan).
Advirtieron que el monto planteado —una reducción de 509 a 90 millones de pesos— dejaría al estado sin capacidad real de promoción turística.
El planteamiento ocurre mientras la Secretaría de Cultura tendría un incremento de 125 por ciento para el próximo año, al pasar de 205 a 460 millones de pesos.
El sector hotelero reconoció la importancia del impulso cultural, pero pidió equilibrio para no comprometer la visibilidad turística del estado. “Necesitaríamos mayor presupuesto para hacernos visibles”
La presidenta de la Unión de Empresarios Hoteleros de la Región Cultura y Aventura AC, María Xóchitl Guzmán Segundo, confirmó que el sector se mantiene atento al proceso de discusión presupuestal e hizo un llamado respetuoso a que se considere un ajuste al monto destinado a Turismo. “Esperemos que sí se considere un mayor presupuesto para la Secretaría de Turismo”, señaló.
Destacó que el crecimiento en Cultura es positivo y reconoció el trabajo de la titular de esa dependencia, pero insistió en
Inicia la comercialización de los tradicionales carritos, rumbo al Día del Niño Perdido
IRIS ROMÁN TUXPAN
La temporada de tradición ya comenzó. Comerciantes locales iniciaron oficialmente la venta de los tradicionales carritos de cartón, una de las costumbres más esperadas por niñas, niños y familias previo a la celebración del Día del Niño Perdido. Desde tempranas horas, puestos en distintos puntos de la ciudad comenzaron a exhibir carritos de todos los tamaños, colores y diseños, elaborados de manera artesanal con cartón, luces y detalles decorativos que evocan la esencia de esta festividad que año con año fortalece la identidad cultural tuxpeña. Los vendedores reportan algo de demanda, destacando que muchas familias buscan

comprar con anticipación para evitar quedarse sin su carrito. Algunos modelos cuentan con temáticas de personajes animados, equipos deportivos, carros de bomberos, patrullas y ambulancias, mientras que los más tradicionales mantienen colores clásicos y detalles hechos a mano. Comerciantes expresaron su entusiasmo por mantener viva la costumbre que pasa de generación en generación. “Para nosotros no es solo negocio, es
la necesidad de fortalecer también la promoción turística.
“Necesitaríamos mayor cantidad para darle promoción al estado, para que nos hagamos visibles y darle continuidad a toda la cuestión turística”.
Guzmán Segundo confió en que el tema será atendido por el gobierno estatal. “Seguramente la gobernadora lo va a considerar también”.
El empresario hotelero Marcos Suárez compartió la inquietud del sector ante la propuesta de reducción. Afirmó que la noticia generó extrañeza entre los prestadores de servicios, pues Veracruz compite con estados que destinan fuertes inversiones a la promoción turística.
Señaló que el turismo es una competencia directa entre entidades federativas, y sin promoción, Veracruz quedaría rezagado: “Todos los estados ofertan sus productos turísticos, sus ferias, sus eventos… Nosotros estaríamos totalmente a la deriva sin ninguna promoción”.
El sector hotelero sostuvo que el turismo ha sido históricamente un motor económico para el estado, por lo que piden que el análisis presupuestal tome en cuenta el impacto que tendría una reducción de esta magnitud en la actividad turística y, en consecuencia, en miles de familias que dependen de ella.


parte de la tradición de Tuxpan. Cada carrito lleva horas de trabajo y mucho cariño, porque sabemos que para los niños es especial”, comentó uno de los vendedores.
La venta se mantendrá durante los próximos días y se espera que el mayor movimiento se registre conforme se acerque la fecha del Día del Niño Perdido, cuando familias completas recorren las calles con velas y carritos como símbolo de fe, esperanza y unión.

Esta entrega de artículos básicos permitirá a las familias continuar su proceso de recuperación
Poza Rica.- La delegación de la Cruz Roja Mexicana en Poza Rica realizó la entrega de kits de higiene, salud y limpieza, además de despensas, a familias de la colonia Morelos en Poza Rica y la comunidad de Corralillos en el municipio de Tihuatlán, como parte de las acciones previas al censo que permitirá identificar a más hogares que aún requieren apoyo.
En la colonia Morelos, personal de la Cruz Roja recorrió las viviendas para entregar artículos básicos que permitan a las familias continuar su proceso de recuperación. Cada apoyo, indicaron, representa un impulso para los hogares que siguen enfrentando las secuelas de la reciente contingencia.
Mientras tanto, en la comunidad de Corralillos, perteneciente a Tihuatlán, los brigadistas llevaron kits de limpieza, salud e higiene a las familias que permanecen en situación vulnerable. Las entregas, señalaron, son un recordatorio de que la institución se mantiene cerca de la población en los momentos más difíciles.
La Cruz Roja destacó que estas acciones permiten llegar a rincones donde la ayuda sigue siendo necesaria, fortaleciendo así el acompañamiento a las comunidades afectadas. Las familias reconocieron la importancia de recibir estos insu-


mos, especialmente en un periodo donde la recuperación avanza de manera desigual. Las autoridades de la delegación señalaron que el censo en marcha ayudará a ampliar el alcance de los apoyos y garantizar que ninguna

familia quede sin ser atendida. Reiteraron que continuarán visitando colonias y comunidades mientras exista necesidad, manteniendo firme el compromiso de caminar junto a la gente.

Derrame está generando mal olor, el cual afecta a vecinos del sector Agustín Melgar
AGENCIAS TIHUATLÁN
Autoridades auxiliares de la localidad Totolapa reportaron este día una fuga de hidrocarburo, el cual genera fuerte olor que afecta a vecinos cercanos al lugar.
Refieren que, las familias que se localizan en el sector Agustín Melgar reportaron al agente municipal Federico Ordóñez
El motivo es la reciente contingencia que aún enfrenta gran parte de la población afectada
AGENCIAS POZA RICA
El Ayuntamiento de Poza Rica confirmó la suspensión del desfile cívico-deportivo del 20 de noviembre, esto debido a la contingencia que enfrenta la ciudad tras la reciente inundación, la cual mantiene a gran parte de la población afectada y concentrada en las labores de recuperación.
Cada año, este evento reunía a cerca de 30 grupos de estudiantes y diversas organizaciones civiles, quienes marchaban junto a elementos del Ejército Mexicano en una de las participaciones más concurridas del calendario cívico local.
El recorrido tradicionalmente se desarrollaba sobre el bulevar Adolfo Ruiz Cortines, vialidad que actualmente presenta afectaciones por la acumulación de
sobre este problema, donde el aceite escurre sobre parte de una banqueta y terreno, cuya afectación puede aumentar si no se controla la fuga. Al mismo tiempo le notificaron a Protección Civil, con el objetivo de acordonar el área ante posible accidentes de la población.
Recordaron que, el pasado mes de septiembre se registró una fuga de aceite en un ducto de Petróleos Mexicanos en un terreno moscoso del mismo sector, el cual originó un fuerte escurrimiento del hidrocarburo por el arroyo Totolapa. Agregan, al igual que este percance, en el anterior la empresa no atendió del todo los daños registrados en el ecosistema y varias zonas urbanas, situación donde deben aplicar sanciones severas para erradicar las fugas frecuentes.
lodo, escombros y daños en la infraestructura, lo que imposibilita su utilización para actividades masivas. Autoridades municipales señalaron que la prioridad en estos momentos es garantizar la seguridad de la ciudadanía, así como continuar con las acciones de apoyo a las familias damnificadas, por lo que la logística del desfile resultaba inviable.
Finalmente, se informó que, aunque la conmemoración oficial de la Revolución Mexicana no se realizará como cada año, el gobierno local invitó a la población a mantener viva la memoria histórica desde sus hogares mientras continúan las labores de restablecimiento en la ciudad.



Tuxpan participa en el Tianguis de Pueblos Mágicos 2025 con sólida promoción turística
»IRIS ROMÁN
TUXPAN.- Tuxpan volvió a colocarse en los ojos del turismo nacional tras su participación en el Tianguis de Pueblos Mágicos 2025, evento realizado recientemente en Pachuca, Hidalgo, donde representantes del sector turístico del municipio llevaron la riqueza natural
y cultural de esta región veracruzana a visitantes y profesionales de toda la República.
Durante una entrevista, José Ángel Pineda, integrante de Protur Tuxpan y titular de la agencia Pineda Travels, expresó que este encuentro fue una gran oportunidad para fortalecer alianzas y promover el destino ante un mercado cada vez más competitivo.
“Tuxpan estuvo presente con fuerza, promoviendo nuestras playas, gastronomía y experiencias turísticas. Participamos también en colaboración con otros municipios y destinos, impulsando el nombre de Veracruz y de los Pueblos Mágicos del estado”, comentó.

Pineda resaltó que las tareas de promoción no se detienen, pues es fundamental mantener a Tuxpan como un destino atractivo para el cierre del año, uno de los periodos más importantes en llegada de visitantes.
“Diciembre es temporada alta y estamos trabajando en campañas conjuntas con todo el sector turístico para que la gente tenga claro que Tuxpan está preparado para recibirlos”, aseguró. El representante destacó que la participación en el Tianguis dejó resultados positivos, tanto en posicionamiento como en el interés generado por tour operadores y agencias de viaje.

A lo largo del evento se realizaron 66 pruebas entre heats y finales, en todas las categorías, dos modalidades y ambas ramas
»IRIS ROMÁN
TUXPAN.- La 33ª Regata Nacional Tuxpan 2025 llegó a su fin con gran éxito en la pista de canotaje de Santiago de la Peña, donde se registró un lleno total durante las competencias.
A lo largo del evento se realizaron 66 pruebas entre heats y finales, en todas las categorías, dos modalidades y ambas ramas. El ambiente se mantuvo dinámico gracias a la participación del narrador que animó cada carrera.
Los organizadores agradecieron al Lic. Manuel Cortina Martínez por las facilidades otorgadas para el uso de las instalaciones, así como al público que asistió y apoyó a los deportistas.
El evento fue calificado por puntos, quedando la tabla final de la siguiente manera: 1er lugar: Club Jaguares de Querétaro; 499 puntos – 18 medallas de oro, 13 de plata y 15 de bronce.
2º lugar: Club A.M.C. de Tuxpan; 362 puntos – 4 medallas de oro, 10 de plata y 11 de bronce y 3er lugar: Club de Canotaje Tuxpan; 331 puntos – 7 medallas de oro, 12 de plata y 5 de bronce.
La competencia se desarrolló sin contratiempos y reafirma a Tuxpan como una sede destacada para eventos deportivos nacionales.

»AGENCIAS
XALAPA.- La Procuraduría Federal del Consumidor en Veracruz informó que las principales quejas durante el Buen Fin estuvieron relacionadas con precios confusos, promociones poco claras y retrasos en la entrega de productos, señaló el delegado Marcos Castillo López.
Castillo López indicó que el mayor volumen de ventas y consultas se concentró en productos electrónicos.
“Lo que más demanda tiene en este evento del Buen Fin es la electrónica: las pantallas, los celulares, la línea blanca, la ropa, zapatos y electrodomésticos”, explicó.
El delegado detalló que entre las quejas más frecuentes se registraron errores en los precios exhibidos. “Ha habido situaciones de etiquetado en los precios, que hay un precio que tiene alguna confusión”, señaló.
Otra problemática recurrente ocurre después del evento, cuando inician las entregas.
“Normalmente después de la edición del Buen Fin, cuando ya viene la entrega, no se efectuó en los tiempos que ahí les marca o llegó el artículo un poquito diferente o dañado”, añadió.
Castillo López precisó que, aunque estos casos se presentan cada año, no representan un número elevado. Afirmó que la Profeco mantiene atención inmediata para evitar afectaciones a los consumidores durante y después del Buen Fin.

AGENCIAS
CIUDAD DE MÉXICO
El Corona Capital 2025 cerró su celebrada 15 edición, con 82 mil 601 personas en la Curva 4 del Autódromo Hermanos Rodríguez, donde Deftones, Weezer, James y AFI hicieron lo suyo.
¡LIBERADORES! DEFTONES
IMPULSA EL FINAL DEL CC
Faltaban diez minutos para que Deftones apareciera y todo estaba listo. Miles de personas gritando su nombre: “¡Deftones, Deftones!”, se escuchaba en el aire, que atravesaba el humo denso de las máquinas que preparaban la atmósfera para que aparecieran los californianos en la tarima.
Hubo un ambiente sofocante, aplastante, por la marea de gente y también por la neblina que se iluminaba de violeta por las luces neón sobre la pantalla principal. Cuatro columnas ya estaban listas para la acción, todas introducidas entre los instrumentos.
Entonces se apagaron las luces y el grito estalló, se liberó el estrés de la espera, se olvidó el cansancio de tres días de festival y las guitarras lo fueron todo. Pero, más aún, fue sólo la voz de Chino Moreno y el grito de amor de México para él: “¡Chino, Chino, Chino!”, que el vocalista, con su barba de chivo y cabello largo, respondió: “¿Qué pasa México?”.
Todo fue un discurso de libertad, como Deftones tiene acostumbrada a su gente. Sí, con ambiente dramático propiciado por los bajos oscuros y potentes, por la guitarra triste lenta, que ruge, pero con letras que incitan el dejar, el soltar, reflexionar.
Como escapar del ruido cuando tocaron My Own Summer, pero escapando del ruido del mundo transformado en música, un tema de aislamiento que en colectivo, en el festival, parece cambiar su significado.
Needles and Pins y Sextape continuaron el repertorio, casi poéticamente, entre vasos de cerveza volando muy

alto, derramando líquido sobre los que sólo disfrutaban, y en las pantallas, cientos de palomas emprenden el vuelo, visuales que cautivan, una mujer flotando en el mar, las olas que la arrastran hasta la orilla. Un juego de contrastes, la agresividad musical que emana de la vulnerabilidad y hace que el público cante, se abra y, por un momento, sean sólo esos miles de almas y Deftones, en un diálogo que termina con el reloj a las 23 horas.
WEEZER DESEMPOLVA MÁS QUE RECUERDOS
Woooo u ooooo, woooo u ooooo”, y el público respondía igualmente, cantando a coro. Así invadió Weezer el escenario principal del Corona Capital 2025, con sus riffs de guitarra inconfundibles, que recuerdan a los 2000, frente a un público que no se dejaba abatir por los tres días de actividad y resistía escuchando firme a una de las últimas bandas de esta edición, la de Los Ángeles, California.
Rivers Cuomo, con lentes de armazón enorme, su típica camisa ahora con diseño colorido y una camisa básica blanca debajo. Cualquiera lo pasaría viéndolo cantar balada rock al inicio del show, pero rápidamente Weezer se transforma y una guitarra agresiva ruidosa que cruje comienza a sonar, cortesía de Brian Bell. Así, en vaivén, toda su presentación en el último día de actividades.
Yendo y viniendo entre coros románticos, coros emocionales de amor, con la guitarra amigable, hasta el estribillo, ponían a cantar y brincar a todo el público, que sacudía más que sólo la cabeza: ponía a menear los brazos, a colgarse de a lado y hasta lanzar la cerveza.
Entonces llegó uno de sus grandes clásicos, y no, no se trata de un rock imponente, sino de su balada rock pop Island in the Sun, que puso a cantar a toda su gente, desde el que se encontraba en primera fila y podía verse mirando al grupo ilusionado, sujetado a la valla en las pantallas del escenario, hasta los que descansaban de un largo día en los pastos más alejados a la tarima.
Algunos que estaban acostados, soñando con los temas de los angelinos de fondo, hasta se despertaron, se levantaron del pasto, se sacudieron un poco y empezaron a cantar, a bailar y a filmar el momento. Justo ahí Rivers agradeció.
¡Méxicoooooo! ¡La Ciudad de Méxicoooo!”, gritó fuerte y largo. “¡Qué linda ciudad, mi sueño es México!”, insistió el vocalista cantando. “Mucho gusto”, dijo, todo en español, lo que provocó ternura en las fans.
Weezer encadenó en todo el show

como Buddy Holly, Say It Ain’t So e Island in the Sun, acompañado por el amor de sus fans. Todos los temas hicieron que todo el público levantara las manos al ritmo de la banda como si realmente pudieran, como sugieren las letras: escapar por un instante a un lugar sin preocupaciones.
ADELITA Y PUNK ROCK
Como PinkPantheress terminó decepcionando por su cancelación, Adéla tomó su lugar. La trainee que no logró terminar en la alineación final de Katseye fue la parte rosa en la vorágine oscura que estaba por caer en el Autódromo Hermanos Rodríguez.
Y le tocó día cañón, porque tenía que convencer a los novios de las morras que sí querían ver algo de pop, incluso que compraron para sólo verla a ella. No hubo banda en vivo, sólo ella para Superscar y SexOnTheBeat.
Apenas 30 minutos, un montón de nervio, pero más actitud para no decepcionar a sus seguidoras, muchas de ellas morras que llevaban alguna camiseta de Katseye, porque hubieran deseado tenerla en la alineación final. Dos peluches simis y un ramo de flores para debutar en festivales mundiales.
AFI ya fue cosa seria, aunque la neta había poca banda punk que llegó a verlos, la mayoría eran parte de la escena generacional que llegó con Decemberunderground. Davey por fin debutó su nueva apariencia, porque como Ethan Hawke, es un maestro de las caretas, así que en su paso pospunker la base y el bigote son parte de su nuevo yo.
El setlist no fue tan diferente al de su showcase de enero en House of Vans. Sólo metieron las rolas de Holy Visions y Behind the Clock para empezar el ciclo del nuevo disco Silver Bleeds The Black Sun…
Lo realmente valioso llegó en tres partes, al menos el tesoro para la raza old school que estuvo frente al escenario y cerca de la pasarela armando un slam, porque no llegó a moshpit como algunos confunden. Como sea, la neta se puso chido cuando sonó Dancing Through Sunday, The Boy Who Destroyed The World y The Days of the Phoenix. Es lo más cerca que estuvimos del viejo AFI metido en el punk rock y hardcore. Pero también se agradeció estar en la parte emo de Silver and Cold y Miss Murder, que por más que se quejen los viejos que añoran las eras de The Art of Drowning y Black Sails in the Sunset, le permitieron a la banda llegar a festivales tan grandes como el Corona Capital. Después de todo, vivimos en tiempos donde ya todos podemos convivir y estuvo cool cantar Miss Murder con la raza nu metalera y geek que arribó a ver a Deftones y Weezer, consecutivamente. También había emos, en especial un par de vatos que replicaron el megafleco de Davey Havok de tiempos del álbum Decemberunderground.
Tampoco hubo lluvia de chela, no porque fuéramos ya aburridos, sino porque duele aventar 200 varos a la humanidad de algunos carnales que terminan bañados sin más. Terminó muy cañón el show y la gente se dispersó, algunos a pisotear, comer, llenar y vaciar el tanque o ver a James en la comodidad de las lonas frente al Doritos.

Somo James, nunca tocamos el mismo setlist, lo cambiamos cada noche para que puedan escuchar canciones que jamás hemos tocado”, dijo Tim Booth antes de cantar Beautiful Beaches. Y como ya es costumbre, el viejo inglés se bajó a barricada para cantar a la gente.
Y si había un buen de fans de ellos, pero muchos eran de los Deftones, esperando pacientes el regreso de Chino Moreno y compañía después de nueve años de aquel Knotfest. Sin embargo, no le hicieron el feo a escuchar rolas tan clásicas como Say Something y Laid. Estuvo cool su set, solamente que… pues con Weezer era otra de las paradas obligatorias del festival.
Martes 18 de Noviembre de


del avión, incluso recostándose en los asientos.
Un llamado de atención en pleno vuelo
Los músicos argentinos Ca7riel y Paco Amoroso enfrentaron un inconveniente a su llegada a Estados Unidos después de grabar un videoclip a bordo de un vuelo comercial, lo que derivó en la intervención de personal de seguridad aeroportuaria.
El episodio ocurrió durante un viaje dentro del territorio estadounidense, cuando los artistas aprovecharon el trayecto para registrar imágenes de su nueva canción “Chapulín”.
En los videos difundidos en redes sociales, se observa a ambos cantando, bailando e interactuando con la cámara mientras se desplazan por el pasillo
La situación se tensó cuando una azafata intentó pedirles que regresaran a sus lugares. En las imágenes se la escucha diciendo: “Don’t touch me” mientras intenta frenar el rodaje.
Según se aprecia en los clips, el personal de cabina habría solicitado en más de una ocasión que respetaran las normas de seguridad del vuelo.
En vuelos comerciales, está prohibido permanecer de pie o circular por el pasillo durante momentos no autorizados por la tripulación, así como realizar actividades que puedan obstaculizar el servicio o molestar a los pasajeros, una normativa regulada por la Administración
Kim Kardashian llora al reprobar el examen de abogacía
AGENCIAS
Kim Kardashian, volvió a abrir las puertas de su vida privada para mostrar un lado mucho más vulnerable: el de una estudiante frustrada ante un sueño que se resiste.
La empresaria, estrella de televisión y ahora también actriz, compartió un video en el que documenta las semanas previas a presentar el examen de abogacía de California. Un desafío que, una vez más, no logró aprobar.
Kim Kardashian habla sobre su examen de abogacía
El pasado 16 de noviembre, Kim publicó un video profundamente personal donde documentó las dos semanas previas a presentar el complejo examen que le permitiría ejercer formalmente como abogada. Sentada en su cama, llorando y visiblemente agotada, la fundadora de SKIMS mostró algo más que cansancio: mostró cuánto significa para ella este objetivo. He compartido mucho de este viaje contigo…” escribió al inicio del mensaje que acompaña el video. “El 7 de noviembre descubrí que no pasé la barra. Fue decepcionante, pero no fue el final. Este sueño
significa demasiado para mí como para alejarme de él”.
Kim Kardashian llora al prepararse para su examen
El video, que rápidamente se viralizó, retrocede a dos semanas antes del examen y revela el intenso trabajo detrás de la prueba: cinco preguntas de ensayo de una hora cada una, un test de desempeño de 90 minutos y 200 preguntas de opción múltiple. Un reto que, según confiesa, la llevó a sentir que “su cabeza iba a explotar”.
Cada vez que siento que estoy un paso adelante, algo intenta detenerme”, se le escucha decir entre lágrimas. “Una parte de mí solo quiere parar… todavía me queda tanto por recorrer”.
Aun así, no se rindió. Con sus cuatro hijos de vacaciones, aprovechó cada minuto para estudiar. El día previo al examen se mostraba optimista: “Me siento preparada”, afirmó frente a la cámara. Kim Kardashian reprueba el examen de abogacía
El 7 de noviembre recibió la noticia: no había aprobado. Ese mismo día, coincidió con el estreno de All’s Fair, la serie de Hulu donde interpreta a una abogada de divorcios. Con ironía —y un toque de honestidad dolorosa— escribió en Instagram:
Intervención de seguridad en el aeropuerto
Al aterrizar, el grupo fue recibido por autoridades aeroportuarias estadounidenses. En otro video tomado por su equipo se puede ver a los artistas siendo retenidos e interrogados por agentes de seguridad mientras cuatro oficiales observan y controlan la zona.
Aunque se ha mencionado informalmente que personal del FBI se habría involucrado, hasta ahora no existe confirmación oficial de dicha intervención.
En Estados Unidos, incidentes relacionados con comportamiento disruptivo en aviones suelen ser atendidos por la seguridad aeroportuaria (TSA) y por la policía del aeropuerto correspondiente.
Personas del entorno de los músicos
Bueno… todavía no soy abogada, solo interpreto a una muy bien vestida en la televisión”.
La decepción no opacó su determinación. Kim dejó claro que piensa seguir adelante. “Llevo seis años en este camino. No hay atajos, no hay rendirse. Solo más estudio y más determinación”.
Kim Kardashian como abogada
El sueño de Kim de convertirse en abogada no surgió de la nada. Su padre, Robert Kardashian, fue un reconocido abogado en Los Ángeles y formó parte del equipo legal de O.J. Simpson. Inspirada por su legado, Kim se inscribió en 2018 en un programa alternativo de derecho, que combina estudio autodidacta y pasantías bajo la supervisión de un abogado.
En 2021 logró aprobar el examen preliminar de abogacía, un paso importante que la autorizaba a continuar hacia el examen general. También aprobó el Exame n Multiestatal de Responsabilidad Profesional (MPRE) en marzo pasado.
Este último examen, el definitivo, era la meta más ambiciosa. Aunque esta vez no logró pasar, su reacción dejó claro que no piensa detenerse:
No alcanzar las expectativas no es un fracaso, es combustible”, escribió. “Estuve tan cerca que ahora solo quiero intentarlo otra vez”.
Kim sabe que la mirada pública siempre está sobre ella, pero también entiende el
aparecen mediando con las autoridades y explicando la situación para facilitar su ingreso al país. Finalmente, el proceso concluyó sin mayores consecuencias y los artistas pudieron continuar con su itinerario.
Promoción en tiempos de inmediatez Ca7riel y Paco Amoroso se han caracterizado por una propuesta creativa que mezcla música urbana, elementos teatrales y una estética rupturista. La grabación improvisada a miles de metros de altura parece alinearse con esa identidad, aunque esta vez rozara los límites normativos del transporte aéreo. Hasta el momento, ninguno de los músicos ha hecho declaraciones públicas sobre lo ocurrido. Su gira continúa en Estados Unidos mientras preparan el lanzamiento oficial de Chapulín.
poder de mostrar vulnerabilidad. Por eso decidió compartir el resultado antes de que se hiciera oficial, según reportó TMZ: quería ser sincera con quienes han seguido su proceso desde el primer día. El camino para convertirse en abogada ha sido largo, complejo y emocionalmente desafiante. Pero si algo ha demostrado Kim Kardashian, es que cuando un sueño significa tanto, ningún tropiezo es suficiente para apagarlo. Y ella, fiel a su estilo, seguirá intentándolo hasta conseguirlo. Si quieres saber más sobre su carrera como abogada, no te pierdas el siguiente video.

AGENCIAS
Algunas selecciones van a continuar con su preparación para el Mundial 2026 y otras solo afrontarán un compromiso más de carácter amistoso, pero habrá más representaciones que en esta última fecha FIFA de este martes se jugarán el todo o nada para clasificar al magno evento que se efectúa cada cuatro años.
De los 48 espacios que había disponibles para este Mundial ya hay 34 lugares ocupados una vez que ya clasificaron Argentina, Japón, Nueva Zelanda, Uzbekistán, Corea del Sur, Jordania, Australia, Ecuador, Brasil, Colombia, Paraguay, Uruguay, Marruecos, Túnez, Egipto, Argelia, Ghana, Cabo Verde, Sudáfrica, Qatar, Inglaterra, Arabia Saudita, Qatar, Costa de Marfil, Senegal, Francia, Croacia, Portugal, Noruega, Países Bajos y Alemania, además de los tres países sedes México, Estados Unidos y Canadá.
Concacaf da 3 boletos a la Copa del Mundo
Este martes se definirán los tres boletos directos de la Concacaf cuando se juegue la última fecha de las eliminatorias. Los líderes de cada uno de los tres grupos avanzarán de manera directa al Mundial.
En el Grupo A, Surinam, con +5 goles, y Panamá, con + 2, tienen 9 puntos cada uno. Surinam visitará a Guatemala y Panamá recibirá a El Salvador para definir al líder y ganador del pasaje mundialista. El equipo que termine segundo se va al repechaje.
En el Grupo B, Curazao es líder con 11 unidades, seguido de Jamaica con 10 puntos. Con esto el compromiso a celebrarse en Kingston será de vital importancia ya que jamaiquinos y curazoleños medirán fuerzas. Todo es claro, quien gane va al Mundial, aunque el empate también beneficia a Curazao.
¿Miguel Herrara y Costa Rica aún pueden ir al Mundial 2026?
En el sector C, Honduras, con +3, y Haití, con +1, son punteros con ocho unidades cada uno seguidos de Costa Rica,

que tiene seis con +2. La batalla para el ir al Mundial es la siguiente: los ticos le harán los honores a catrachos y Haití recibirá a nicaragüenses. Los dirigidos por el mexicano Miguel Herrera deberán ganar sí o sí y si los haitianos no triunfan estarán en el Mundial y en caso de que los isleños ganen, serán los costarricenses segundos a la espera de colarse al repechaje como uno de los dos mejores segundos lugares. Honduras estará en la Copa del Mundo en caso de ganar y si se da otro resultado deberá esperar para conocer si va al certamen o espera por la repesca o hasta podría quedar eliminado.
Por ahora los dos mejores segundos lugares de la eliminatoria de Concacaf que irían al repechaje son Jamaica con 10 puntos y Panamá con nueve, mientras que Haití es segundo, pero con ocho puntos y ahorita ni siquiera estaría en la repesca.
¿Qué equipos de Europa pueden clasificarse a la Copa del Mundo 2026 en la última fecha FIFA?
En las eliminatorias europeas falta poco por definirse, cabe subrayar que los líderes de cada uno de los 12 sectores acceden de manera directa al Mundial, por ahora ya están en el magno evento las representaciones de Inglaterra, Francia, Croacia, Portugal, Noruega, Alemania y Países Bajos (Holanda).
Este martes se podrá sumar España, que enfrentará a Turquía en el Grupo


E. Prácticamente la Furia Roja está en el Mundial incluso con una derrota gracias a su mejor diferencia de goles, para que vaya a la repesca tendría que caer por goleada de más de 10 tantos de diferencia, algo que luce impensable y todo indica que los turcos irán al repechaje.
En el sector B se aprecia algo similar, Suiza es líder con 13 puntos y +12 goles, seguida de Kosovo, que cuenta con 10 puntos y +1 gol a favor. Los kosovares recibirán a los helvéticos y si quieren el pasaje al Mundial tendrán que ganar por una goleada prácticamente inviable, así que los suizos estarán en la próxima Copa del Mundo y Kosovo jugará los playoffs.
Escocia y Dinamarca se juegan el pase a la Copa del Mundo
En el escuadrón C la batalla será a matar o morir cuando en Glasgow jueguen Escocia y Dinamarca por una clasificación mundialista. Los daneses son líderes con 11 puntos, uno más que los escoses, por lo que les bastaría un empate para estar en el Mundial, mientras que a los británicos solo les es suficiente ganar. Quien quede en segundo va al repechaje. En lo que respecta al Grupo H, Austria recibirá en Viena a Bosnia Herzegovina. Los austriacos tendrán en sus manos el
boleto mundialista sin escalas ya que son líderes con 18 puntos, por 16 de los bosnios, que tendrán que ganar sí o sí o bien deberán afrontar la repesca. Finalmente, en el sector J, Bélgica querrá certificar su presencia en el Mundial a través de una victoria contra Liechtenstein. Si empatan o pierden los belgas tendrán que esperar a lo haga Macedonia del Norte y Gales para saber si van directos a la Copa del Mundo o bien al repechaje.
Bélgica es líder con 15 puntos y +15 goles, seguido de Macedonia con 13 puntos y +9, y de Gales, que ostenta 13 unidades y una diferencia de +4. Galeses y macedonios chocarán entre sí en Cardiff, donde los visitantes tendrán la obligación de no perder para al menos jugar los playoffs de la UEFA, pues Gales pase lo que pase jugará la repesca gracias a su ranking en al Nations League, aunque si gana y pierde Bélgica los británicos entrarán directos en el Mundial 2026.
Los mejores segundos lugares de UEFA van a playoffs por un boleto al Mundial 2026
Todos los segundos lugares de cada uno de los 12 grupos van a los playoffs de la UEFA para buscar un pasaje mundialista, además de las cuatro mejores selecciones ubicadas en el ranking de la Nations League y que no terminaron en el segundo puesto de la fase de grupos de la eliminatoria de la UEFA.
Por ahora en los playoffs europeos para buscar uno de los últimos cuatro boletos mundialistas se encuentran: Eslovaquia, Ucrania, Irlanda, Polonia, Italia Albania y República Checa, selecciones que terminaron en el segundo sitio de su escuadrón, además de Irlanda del Norte, Suecia y Rumanía, representaciones que gracias al ranking de la Nations League afrontarán la repesca en el viejo continente con todo y que no finalizaron segundos de su grupo. Se tienen que juntar 16 selecciones en total para conformar los playoffs, lo cual se conocerá este martes.



Javier Aguirre no quiere en su equipo a jugadores con la piel delgada. El tenso ambiente, con la falta de resultados entre la Selección Mexicana que merman la relación con la afición Tricolor, puede generar una presión extra al plantel del “Vasco” pero él lo tiene claro: si no aguantan la crítica, no sirve.
“El que no sepa estar sentado aquí, o salir al campo con ochenta, noventa o con cuatro aficionados en contra, y que no acepte la crítica, que no esté preparado para ser sometido a juicio público, no sirve para esto. Yo así lo veo. La más fácil para mí es escudarme en pretextos, en arbitrajes, en que los jugadores no me entienden, etc. y al final esto da vueltas
Agustín Moreno critica el desarrollo de Rodrigo Pacheco
AGENCIAS
Un par de años en el profesionalismo y Rodrigo Pacheco parece estacando por encima del top-200 de la ATP. Pese a tener apenas 20 años de edad, el tenista mexicano se ha quedado por debajo de las expectativas que generó a su llegada al circuito luego de ser el #1 del mundo a nivel junior, viendo como otros jugadores de su generación ya han irrumpido en los Grand Slams y ocupan las primeras plazas en la clasificación varonil.
Agustín el ‘Bebé’ Moreno, uno de los mejores tenistas en la historia del país y quien actualmente funge como entrenador en la Universidad de Loyola Marymount, considera que Pacheco Méndez se equivocó al no haber pasado por el nivel universitario en la NCAA, donde pudo haberse desarro-
y la mentira siempre regresa. Como digo yo a mis jugadores: puedes engañar al entrenador, puedes engañar incluso a tu familia, a tu representante, a la afición, a la prensa, pero no al espejo“, dijo en conferencia de prensa previo al duelo ante Paraguay en el Alamodome.
Javier Aguirre pide a los jugadores de la Selección Mexicana soportar la crítica y abucheos
Aguirre agregó que, además de soportar la crítica, quiere que sus jugadores representen de la mejor manera a su afición y sean un ejemplo para ellos, tanto dentro como fuera de la cancha.
“Ahí es donde donde necesitamos equilibrio emocional, necesitamos piel gruesa, necesitamos paz mental, y estamos en ello. Que esa conducta que lleven en sus clubes fuera del campo
llado de una mejor forma para competir con los mejores del mundo.
“El tenis universitario le hubiera ayudado, para que su evolución al profesionalismo hubiera sido un poco mejor. Tiene un gran equipo y muchos patrocinios, pero estamos viéndolo que ha perdido muchos partidos en Challengers, y hay jugadores tanto en el tenis colegial como de su edad que están avanzando más que él”, comentó el ‘Bebé’ en plática con ESTO.
Del tenista universitario de Estados Unidos han salido grandes figuras de la actualidad como Ben Shelton, Sloane Stephen, Cameron Norrie o Kevin Anderson.
“Si a nivel colegial eres el mejor, te sales. Si no, haces los cuatro años en la NCAA. Hay más nivel en las universidades de Estados Unidos que en la categoría junior. (Rodrigo) va a ser bueno, pero si se hubiera ido a Europa y luego dos-tres años en el colegial, podría haber tenido un mejor desarrollo”, explicó el también capitán del representativo mexicano de la Billie Jean King Cup.
Ángelica Gavaldón recomien -
de juego, yo soy muy escrupuloso, muy exigente con ello, porque debemos ser ejemplares para nuestra afición, debemos de representarlos y y debemos dar ejemplo, tanto el cuerpo técnico como los jugadores”, agregó.
El Vasco Aguirre revela la relación de Raúl Rangel, Luis Ángel Malagón y Carlos Acevedo
En cuanto al caso específico de Raúl Rangel, quien fue abucheado durante todo el encuentro contra Uruguay porque Aguirre lo eligió en lugar de Carlos Acevedo para jugar en Torreón, el “Vasco” resaltó la armonía que existe en el cuerpo de guardametas.
“Felicité a los tres porteros, tuvieron una gran conducta después en el postpartido, había gestos de complicidad. Hemos logrado que haya una
competencia sana, siempre dentro de un una relación afectiva. Nos une la nacionalidad, la bandera. Hay una gran camaradería entre estos tres“, apuntó.
Asimismo, negó haber hablado con Raúl Jiménez los futbolistas sobre el tema de los abucheos y los gritos en Torreón.
“Hablamos de futbol, del funcionamientos del equipo, de Colombia, Ecuador, Uruguay de lo que se jugó, de lo que se hizo bien y lo que se tiene que mejorar. Nosotros nos dedicamos a jugar futbol a mejorar partido a partido. Más allá de la cuota de gol, creo que hemos ido mejorar, es mi punto de vista. Lo poco que entrenamos se refleja en el campo, no pudimos ganarle a Uruguay, pero hay buenas cosas”, sentenció.

da a Rodrigo Pacheco jugar en el tenis Universitario
En la misma línea se pronunció la histórica ex tenista mexicana, Angélica Gavaldón, quien considera que el hecho de que Pacheco todavía no logre un buen resultado en su carrera, podría hacerlo reconsiderar la idea de probar el sistema universitario.
“Siempre recomiendo que, si no tienes los resultados en el tenis profesional, tienes que ir a la Universidad. Se lo aconsejo a todos los jugadores. A mí cuando me ofrecieron las becas, me resultó una ofensa. Pero yo ya estaba dentro de las
30 mejores del mundo y para mí ya no era una opción, ahí ya sabía que sería algo grande en el tenis. Pero si no tienes los resultados, para mí es un error no tomar esas becas. Ahora ya se apoya muchísimo a los que quieren jugar profesional, antes no era una opción”, refirió Gavaldón.
“No conozco a Rodrigo personalmente. Todavía está joven, todavía está desarrollándose. No sé si hubiera sido mejor tenista o no si hubiera ido a la Universidad. Al menos que ya hubiera jugado los Grand Slams y hubiera tenido un gran resultado, está bien que no fuera al tenis universitario”, finalizó en declaraciones hechas al ‘Diario de los Deportistas’.
Entre los tenistas de la misma edad de Rodrigo Pacheco o menores, hay figuras como el brasileño Joao Fonseca que, con 19 años, ya es el #24 del mundo. Abundan casos en la ATP como el estadounidense Learner Tien (28), el francés Arthur Fils (21) o el norteamericano Ethan Quinn (70).

»AGENCIAS
XALAPA.- Tras las protestas de asesores y estudiantes de la Universidad Popular Autónoma de Veracruz (UPAV) por adeudos y fallas en la plataforma escolar, el secretario de Gobierno, Ricardo
Ahued Bardahuil, afirmó que, con la designación del nuevo rector, Rodolfo Torres, la institución deberá retomar sus procesos administrativos y resolver los atrasos que han generado inconformidad. El funcionario señaló que la falta de titular había frenado diversos trámites, incluidos pagos a asesores, regularización académica y emisión de títulos.
“Ya nombraron al director y ya pueden firmar los asuntos que tienen pendientes de legislación”, dijo.
Ahued Bardahuil explicó que el nombramiento otorgará a la rectoría la facultad para atender los
rezagos acumulados.
“Era un tema pendiente de nombramiento para que tuvieran facultad para poder firmar y otorgar tanto los títulos pendientes como la parte administrativa que quedó pendiente”, puntualizó.
En días recientes, estudiantes reportaron que el sistema los marcaba como “dados de baja”, mientras que asesores denunciaron la falta de pago de varios meses.
Ante ello, Ahued aseguró que existe instrucción directa para resolver estos casos.
El secretario añadió que, con la llegada del nuevo rector, la universidad deberá normalizar el funcionamiento de la plataforma, regularizar pagos y avanzar en la entrega de documentación oficial.
La protesta de asesores y alumnos forma parte de una serie de reclamos que la UPAV ha enfrentado en los últimos meses, principalmente relacionados con irregularidades administrativas y retrasos en trámites académicos.
Pidió ampliar gastos en 2026 para crear plazas y fortalecer áreas de búsqueda e identificación de personas desaparecidas
»AGENCIAS
XALAPA.- La Fiscalía General del Estado solicitó un incremento presupuestal para 2026 con el fin de fortalecer las áreas encargadas de investigar y buscar a personas desaparecidas, ante nuevas obligaciones legales y una plantilla que no ha crecido desde 2015.
La institución recordó que su presupuesto pasó de 1,777 millones de pesos en 2024 a 1,981 millones en 2025, un incremento que consideró insuficiente frente al crecimiento de funciones en materia de búsqueda, identificación e investigación. Señaló que las nuevas obligaciones derivadas de la legislación nacional requieren ampliaciones adicionales para 2026.
La Fiscalía opera con 3,420 plazas autorizadas, cifra que no ha variado en una década, pese a que Veracruz es la cuarta entidad más poblada del país. Para cumplir con la reforma a la Ley General en Materia de Desaparición, requiere 347 nuevas plazas destinadas a la Fiscalía de Investigaciones Ministeriales y a Servicios Periciales.

Estas contrataciones permitirían operar procesos como la activación de la Alerta Nacional de Búsqueda, la generación de fichas con folio RNPDNO, la interconexión con la Plataforma Única de Identidad y la consulta de datos biométricos.
La Fiscalía solicitó recursos para fortalecer unidades como Búsqueda Inmediata, Larga Data, Atención a Víctimas, Análisis de Contexto y Delito Cibernético. Para
ello proyecta 245 plazas adicionales, así como equipo de cómputo, estaciones de trabajo y herramientas de campo. La institución solicitó presupuesto para cubrir resoluciones judiciales pendientes y evitar sanciones. En materia de violencia de género, pidió 1,110 plazas para fortalecer la Fiscalía Especializada en Delitos contra las Mujeres y 40 plazas para integrar la Fiscalía Especializada en Violencia Vicaria.


Se espera normalizar el servicio de recolección de basura a mediados de semana, informó Limpia Pública
ENRIQUE BURGOS
COATZACOALCOS
El servicio de recolección de basura en Coatzacoalcos quedaría normalizado hasta el jueves


20 de noviembre, confirmó el subdirector de Limpia Pública Teodoro Nolasco Román, tras el rezago provocado por el bloqueo en el basurero de Villa Allende. Y es que en el centro de la ciudad aún se observan montones de desechos porque unas de las rutas se desviaron hacia centros de abasto como el mercado
Morelos, donde se acumuló una gran cantidad de basura. Esta modificación retrasó la atención en vialidades como Malpica, Hidalgo y Juárez. De manera gradual el centro recibe atención y el servicio avanza en colonias donde todavía existen puntos críticos.
Nolasco Román, expli -

El municipio no está exento de la violencia, se debe trabajar en crear un ambiente de paz y tranquilidad, señala Obispo
ENRIQUE BURGOS
COATZACOALCOS
Coatzacoalcos no está exento de la situación de violencia e inseguridad en México, por lo que es tarea de todos crear un ambiente de paz y tranquilidad, aseveró el obispo de la Diócesis Rutilo Muñoz Zamora.
En el marco de las manifestaciones del “Movimiento del Sombrero” y “Generación Z”, calificó la situación
como un espiral que parece no tener fin, pero insistió en que, cada ciudadano debe poner de su parte.
En ese sentido, recordó que los obispos en el país dieron a conocer una postura ante las movilizaciones que en lugares como la Ciudad de México se tornaron violentas.
“Qué es lo que estamos viviendo, lo más crítico y difícil, por dónde podemos ir encontrando juntos caminos de solución, la situación económica, la educación, la familia, qué es lo que podemos hacer”, mencionó.
Insistió en que no se trata de una visión pesimista, es la realidad, pero se debe evaluar qué se puede hacer para mejorar.
“Todas las voces que están ahí, algunas más fuertes que otras, pero todos queremos que cambie esta situación.
Coatzacoalcos no estamos exentos, quizás menos que otros estados, digamos no podemos hacer que no pasa nada, sobre todo desde las familias, es mucho lo que podemos hacer ahí”, finalizó.
có que en este momento se enviaron rutas a sectores como Olmeca Río, Olmeca Playa y Gaviotas, entre otros, con un total de nueve circuitos de recolección de los 16 que opera el municipio. Con lo anterior, dijo, la dependencia pretende que parte del personal cumpla doble jornada
Agradecen familias de la
General Anaya gestión y próxima escrituración de sus terrenos, anunciados por la Gobernadora
»ENRIQUE BURGOS
COATZACOALCOS.- Vecinos de la avenida
General Anaya de Coatzacoalcos agradecieron el respaldo del Gobierno Federal, Estatal y municipal para poder contar próximamente con sus escrituras.
Explicaron que llevaban 30 a 40 años sin contar con la certeza jurídica de su terreno, se asentaron cuando todavía había vías de ferrocarril en la zona, ahora ya cuentan con un techo donde vivir.
“Si pues fíjese que hemos batallado bastante, pero pues gracias a Dios con el jefe de manzana que han movido algo y otras personas, estamos feliz y contentos de que nos hayan escuchado nuestras voces, para
para cubrir al menos dos o tres rutas adicionales. El reciente bloqueo en el acceso al tiradero provocó la acumulación de alrededor de 450 toneladas de desechos que quedaron sin destino final, lo que impactó de forma inmediata en la imagen urbana y en el servicio cotidiano.
hacer está gestión de las escrituras, le damos las gracias a Dios y a la gobernadora, todos los que están involucrados en ese sistema en que nos van a entregar las escrituras”, indicó la señora Blanca Rivera.
Las familias, abundaron que el proceso fue largo, pues fueron ignorados en otras administraciones, sin embargo, en esta comenzaron otra vez con las gestiones.
“Entro el presidente Amado Cruz Malpica, fuimos decirle y entonces dijo que iba a ayudarnos, entonces desde ahí empezó la gestión, gracias a ellos y por la investigación que hicieron para desencadenar todo esto que estaba atrapado. Damos las gracias al comité jurídico que tienen aquí en Coatzacoalcos, porque son personas preparadas para hacer todo ese movimiento de la tenencia de la tierra, ya se había trabado otra vez, pero subimos con Rocío Nahle, Rocío Nahle lo subió más arriba”, indicó el señor Víctor Manuel Morales jefe de manzana y uno de los promotores de la escrituración.
Tan solo de Gloria Corrales hasta la calle Cristóbal Colón se estiman más de 120 terrenos que se encuentran sin escrituras.
El fin de semana la gobernadora de Veracruz Rocío Nahle García anunció que la presidenta Claudia Sheinbaum aprobó la donación de terrenos que pertenecían a Ferrocarriles de México, con lo que mil 200 familias de la avenida serán beneficiadas al contar con escrituras.

AGENCIAS SANTIAGO
No desperdiciaron un solo día y, en una carrera contra el tiempo y que se augura áspera, la centroizquierdista Jeannette Jara (26.8 por ciento de los votos) y el ultraderechista José Antonio Kast (23.9), retomaron la campaña tras los comicios del domingo, de cara a la segunda vuelta del 14 de diciembre, cuando se definirá si ella o él será el próximo gobernante de Chile.
Jara tiene un durísimo desafío dada la sumatoria de votos de las tres candidaturas derechistas, que acumularon 50.3 por ciento de los sufragios. Y también los 19.7 puntos que obtuvo el populista Franco Parisi, del Partido de la Gente, quien contra pronóstico remató tercero y cuyos electores son una mezcla variopinta compleja.
Él ganó en las cuatro primeras regiones del norte, donde la actividad principal es la minería, y por donde ingresan los migrantes irregulares, en el centro de la contienda.
Jara retomó el proselitismo en el modesto municipio de La Pintana, en el sur de la capital, donde ayer obtuvo casi 31 por ciento de las preferencias, seguida por Parisi con 26.7.
Acompañada de la alcaldesa democristiana Claudia Pizarro, hizo un compromiso a los vecinos: “En mi gobierno la seguridad pública va a ser una prioridad, no desde el eslogan de la mano dura, sino desde la realidad. Vamos a tener más carabineros en las calles, en las zonas populares donde hay muy pocos”, dijo.
Y es que la inseguridad está en el meollo de las urgencias, más para los vecinos de comunas pobres.
La noche del domingo la oficialista hizo un guiño a los electores de Parisi, afirmó que recogía la

propuesta de eliminar el impuesto de consumo del 19 por ciento a los medicamentos.
Según el analista Cristián Fuentes, “es un electorado volátil, sin fronteras definidas. Tiene los electores del norte que son antiinmigrantes, pero hay también gente de sectores medios aspiracional, individualista. Son anti política y antisistema, es difícil ahí hacer un discurso general”.
Agrega que “de entre los votantes de Evelyn Matthei, por ahí Jara puede captar votos de mujeres, porque Kast es sabido que es misógino”.
En cuanto al balotaje, “esa es otra elección, pero tiene ventaja la derecha. Por muy buena campaña que haga Jara, va a ser muy difícil”.
Kast viajó a La Araucanía, donde obtuvo con 32.5 puntos la primera mayoría, una región capturada por el conflicto entre el pueblo Mapuche y el Estado, y que él promete terminar mediante empleo de la fuerza.
En la elección parlamentaria, el bloque de Kast -Cambio por Chile, con los partidos Republicano,

Nacional Libertario y Social Cristiano, alcanzó 42 diputados, 27 más que en la actual legislatura, lo que los convierte en la principal fuerza individual.
Mientras que Chile Vamos –la alianza histórica de los partidos Demócrata Independiente (UDI), Renovación Nacional (RN) y Evolución Política (Evopoli), pasa de 53 a 34 diputados.
Y en el Senado, que renovó la mitad de los 50 escaños, Cambio por Chile eligió seis para totalizar siete; mientras que Chile Vamos perdió siete y quedó con 18.
“Chile Vamos tiene que replantearse, está en suelo y tiene que cambiar de nombre, entre otras cosas, el piñerismo fue derrotado”, dice el analista, para quien “la derecha está por volver a las bases, que no es más que un neo pinochetismo”.
“El Congreso será complejo, sobre todo la Cámara de Diputados muy fragmentada, con 14 diputados del PDG que se pueden ir para cualquier lado. Si el ganador es Kast, dijo que todo lo que pueda será por decreto”, dice Fuentes.
Trump ve viable atacar a México contra el narco
El presidente de Estados Unidos, Donald Trump, declaró este lunes que no tendría inconveniente en lanzar ataques

ONU
AGENCIAS
El Consejo de Seguridad de la Organización de las Naciones Unidas (ONU), adoptó una resolución estadunidense que detalla el mandato de la fuerza internacional de estabilización de Gaza, tal como se esbozó en el alto el fuego impuesto por el presidente de Estados Unidos, Donald Trump, informó Al Jazeera.
Un vocero de Hamas declaró al medio catarí que el grupo rechaza la presencia de personal militar extranjero en el enclave palestino, afirmando que cambiarían la ocupación israelí por la “tutela extranjera”.
Hubo 13 votos a favor del texto, que Washington calificó después de la votación como “histórico y constructivo”, con abstenciones de Rusia y China y sin vetos. El embajador estadunidense ante Naciones Unidas, Mike Waltz, indicó que “la resolución de hoy representa otro paso significativo que permitirá a Gaza prosperar y un ambiente que dejará a Israel vivir en seguridad”.
El texto, revisado varias veces como resultado de negociaciones de alto nivel “respalda” el plan del presidente Trump, que permitió un frágil alto el fuego entre Israel y Hamas en el territorio palestino devastado por la guerra.
Trump compartió una publicación en Truth Social felicitando al mundo por la “increíble votación del Consejo de Seguridad de las Naciones Unidas”. Destacó que la resolución contempla la creación de una junta de paz, “que yo presidiré”.
Trump también agradeció a todos los miembros del Consejo de Seguridad, incluidos los que se abstuvieron en la votación, así como a otros países que, según él, “apoyaron firmemente la iniciativa, entre ellos Qatar, Egipto, los Emiratos Árabes Unidos, el Reino de Arabia Saudita, Indonesia, Turquía y Jordania”.
El plan de paz autoriza la creación de una Fuerza Internacional de Estabilización (ISF, por su sigla en inglés) que trabajaría con Israel y Egipto y con policías palestinos recién entrenados para ayudar a asegurar las áreas fronterizas y desmilitarizar la franja de Gaza.
contra México si eso detiene el tráfico de drogas hacia Estados Unidos. Luego de que reporteros en la Casa Blanca le preguntaron si aprobaría una operación antidrogas en el territorio mexicano, Trump respondió: “Estoy de acuerdo; lo que tengamos que hacer para detener las drogas. Estuve viendo la situación en Ciudad de México durante el fin de semana. Hay muchí-
simos problemas allá (...) He estado hablando con México. Saben cuál es mi postura”, dijo Trump a periodistas en el Despacho Oval.
“Hemos perdido cientos de miles de personas al año... y gran parte de esas muertes se producen en México. Así que, para que quede claro: No estoy contento con México.”, añadió el mandatario estadunidense a la prensa.
AGENCIAS
CIUDAD DE MÉXICO
En vísperas de la discusión en la Suprema Corte de Justicia de la Nación (SCJN) del proyecto de declaratoria general de inconstitucionalidad de la reforma a la Ley General de Víctimas, el Centro de Derechos Humanos Miguel Agustín Pro Juárez (Centro Prodh), junto con Fundar, Centro de Análisis e Investigación, hicieron un llamado para poner al centro a las víctimas y garantizar la protección efectiva de sus derechos, exigiendo que se restablezca un recurso fijo, etiquetado e irreductible.
Este martes, la Corte discutirá un proyecto de declaratoria general de inconstitucionalidad a cargo del Ministro Giovanni Figueroa Mejía, con el que “tiene en sus manos la oportunidad de asegurar la protección efectiva de los derechos de miles de víctimas en México, exigiendo que se restablezca un presupuesto fijo, etiquetado e irreductible”, señalaron en un comunicado.
El mínimo presupuestal debe garantizarse mediante los instrumentos legales disponibles y debe etiquetarse específicamente para ayuda, atención y reparación, garantizando que no se destine para otros fines, afirmaron.
En 2020, con la reforma a la Ley General de Víctimas (LGV) se eliminó el mínimo presupuestal para la ayuda, asistencia y reparación a víctimas, un derecho previamente conquistado. Previo a esta reforma, en su Artículo 132, fracción I, se incluía la garantía de un recurso mínimo, el cual no podía ser menor del 0.014 por ciento del gasto programable del Presupuesto de Egresos de la Federación (PEF) del año inmediato anterior.
Derivado de lo anterior, el Centro Prodh promovió una demanda de amparo en enero de 2021, en tanto se trataba de una medida regresiva a los derechos de las víctimas. Así, la Primera Sala de la SCJN, en sesión del 13 de marzo de 2024, resolvió por unanimidad el Amparo en Revisión 675/2022, en cuya sentencia declaró que la eliminación de la mencionada garantía presupuestaria en favor de las víctimas constituye una medida regresiva injustificada y violatoria del principio de progresividad, en relación con el derecho humano a una reparación integral del daño.

En este caso, debido a que el Congreso de la Unión no hizo los cambios necesarios para revertir esta medida regresiva, “la SCJN tiene en sus manos, al discutir el proyecto de declaratoria general de inconstitucionalidad, la oportunidad de garantizar los derechos de las víctimas, estableciendo efectos claros y obligatorios, a decir”.
El organismo defensor de derechos humanos subrayó que la eliminación de esta garantía ha tenido un impacto directo y negativo en la capacidad del Estado para atender a las víctimas y que afectó el presupuesto asignado a la Comisión Ejecutiva de Atención a Víctimas (CEAV).
Las organizaciones enfatizaron que la decisión que tiene en puerta el máximo tribunal es central para garantizar el ejercicio pleno de los derechos de las víctimas a la asistencia, protección, atención, verdad, justicia y reparación integral, particularmente ante un contexto donde la violencia continúa en niveles alarmantes y el número de víctimas continúa incrementando, y en el que el Estado no ha logrado consolidar una política de atención digna y adecuada y donde el Sistema Nacional de Víctimas ha sido totalmente olvidado.

AGENCIAS CIUDAD DE MÉXICO
Prácticamente la mitad de los jóvenes de 15 a 29 años de edad en México –la llamada generación Z–están fuera de la población económicamente activa, y la mayoría en esa condición son mujeres.
Datos de la última Encuesta Nacional de Ocupación y Empleo del Instituto Nacional de Estadística y Geografía (Inegi) muestran que de los 30.4 millones de personas en ese rango de edad, 14.5 millones (47.6 por ciento) no desempeñaban alguna actividad económica al primer trimestre de 2025. De esa cifra, 63.4 por ciento eran mujeres.
La quinta parte de los jóvenes en México cuentan con estudios profesionales, y de acuerdo con la Comisión Nacional de Vivienda
(Conavi), 9.8 millones de los de 12 a 29 años (26.1 por ciento) viven en una casa con rezago habitacional. Cristhian Ascencio, académico del Centro de Estudios Sociológicos de la Facultad de Ciencias Políticas y Sociales de la UNAM, destacó que el hecho de que los jóvenes hoy en día no expresen formas habituales de organización política no significa que no se enfrenten una realidad compleja.
Necesidades de justicia e integración
“La generación Z, de hecho las diferentes generaciones, no debe ser vista a la luz de sus expresiones de inconformidad, sino de sus necesidades en términos de justicia e integración social. Si bien no hay en este momento expresiones organizadas de resistencia tan claras entre ellos, eso no significa que no la estén
Jóvenes reflexionan sobre IA y el liderazgo con propósito
AGENCIAS
SAN LUIS POTOSÍ
“Vivimos tiempos en los que la inteligencia artificial y la automatización transforman nuestras formas de trabajo y convivencia, pero también debemos fortalecer la empatía y el liderazgo con propósito. La tecnología solo tiene sentido cuando está al servicio de la humanidad”, se destacó durante el octavo Congreso Universitario Coparmex San Luis Potosí 2025.
la Universidad Autónoma de San Luis Potosí (UASLP), organizadora del encuentro, informó que esta actividad reunió a miles de jóvenes, líderes y emprendedores de instituciones educativas para reflexionar sobre el papel de la inteligencia artificial y la inteligencia emocional en el liderazgo y la innovación.
Claudia Elena González Acevedo, secretaria de Servicios Escolares de la
institución, destacó que esta actividad une el talento juvenil con la visión del sector empresarial en un espacio de diálogo, aprendizaje e inspiración.
El lema del evento, AI-Motion: El poder de crear y emprender con sentido humano, encierra un mensaje urgente sobre la necesidad de equilibrar el avance tecnológico con los valores humanos, añadió.
“Vivimos tiempos en los que la inteligencia artificial y la automatización transforman nuestras formas de trabajo y convivencia, pero también debemos fortalecer la empatía y el liderazgo con propósito”, expresó.
La funcionaria subrayó que los tres ejes del encuentro --inteligencia artificial, inteligencia emocional y emprendimiento con propósito-- representan los pilares del futuro que se busca construir: un desarrollo tecnológico con ética, una inteligencia emocional que fomente la colaboración y un emprendimiento que genere bienestar y sostenibilidad.
Reconoció el compromiso de
pasando mal y que no haya necesidades que atender”, sostuvo. Esa generación, señala, ha experimentado varios procesos de crisis: cambio climático, consecuencias del covid-19, precariedad laboral, falta de acceso a vivienda, expansión del discurso de odio y avance de la ultraderecha en varios países de la región, por citar algunos. Según el Inegi, los jóvenes también enfrentan mayor tasa de desocupación que el resto de la población: mientras 2.5 por ciento de los jóvenes de 15 años y más estaban en esa condición al primer trimestre de este año, entre los de 15 a 29 la cifra fue casi el doble: 4.8 por ciento.
Un análisis de la Conavi indica que la población joven predomina en el mercado de rentas de vivienda, “debido a su incapacidad de costear una o acceder a un crédito hipotecario”.
Coparmex SLP en la formación de jóvenes líderes innovadores y socialmente responsables, destacando que la coincidencia de 12 universidades en este evento demuestra que la educación superior avanza cuando trabaja unida en favor del bien común.
Jaime Chalita Zarur, ex presidente de Coparmex SLP, dijo que es importante resaltar la importancia de que los jóvenes se formen con una visión ética, creativa y comprometida con el desarrollo de la sociedad.
José Homero Garza Rodarte, presidente de la Comisión de Educación de Coparmex, dijo: “Estimados alumnos, promesas del futuro de San Luis y de México, disfruten y aprendan mucho. Los necesitamos muy activos y con un alto nivel de responsabilidad social”. En el evento participaron más de mil estudiantes de instituciones de educación superior, entre ellas la UASLP, Universidad San Pablo, Tecnológico de Monterrey, Universidad del Valle de México, Instituto Salesiano, Universidad Interamericana para el Desarrollo, Universidad Tecnológica Metropolitana, Universidad Cuauhtémoc, Fuerza Migrante y la Universidad Politécnica.
Martes 18 de Noviembre
Martes 18 de Noviembre de
La Organización Mundial de la Salud (OMS) advierte que la resistencia a los antimicrobianos (RAM) causa más de un millón de muertes cada año, una cifra que puede aumentar próximamente si no se actúa para poner fin a esta amenaza, con capacidad para revertir décadas de progreso y poner en riesgo la salud de personas, animales, plantas y ecosistemas.
En la Semana Mundial de Concienciación sobre la Resistencia Antimicrobiana, la OMS y sus socios insta a todos los países a convertir los compromisos políticos adoptados en la Reunión de Alto Nivel de las Naciones Unidas sobre la Resistencia Antimicrobiana de 2024 en intervenciones prácticas eficaces, bajo el lema ‘Actuar ahora: proteger nuestro presente, asegurar nuestro futuro’.
¿Qué es la resistencia antimicrobiana?
La resistencia antimicrobiana se produce cuando las bacterias, los virus, los hongos y los parásitos dejan de responder a los agentes antimicrobianos. Como consecuencia, los antibióticos y otros agentes antimicrobianos pierden su eficacia y las infecciones se vuelven difíciles o imposibles de tratar, lo que aumenta el riesgo de propagación de enfermedades, grave -

dad de la enfermedad e incluso la muerte.
“Todos los países se enfrentan a la resistencia antimicrobiana.

Los patógenos resistentes a los medicamentos están aumentando en todas partes, y cuanto menor sea el acceso de las perso -
nas a la prevención, el diagnóstico y el tratamiento adecuado, mayor será la probabilidad de que sufran infecciones resistentes a los medicamentos”, afirma el director de resistencia antimicrobiana de la OMS, Yvan Hutin.
En este sentido, la OMS demanda una acción coordinada por parte de responsables políticos, personal sanitario, veterinarios, agricultores, profesionales del medio ambiente y del tratamiento de aguas residuales, investigadores, sociedad civil y comunidades. “Ya sea un administrador hospitalario que crea un equipo de gestión de antimicrobianos o un agricultor que adopta prácticas sostenibles de gestión de residuos, cada acción cuenta”, asegura.
A través de esta campaña, busca aumentar la concienciación y la comprensión de la RAM; promover la acción global para abordar la aparición y propagación de patógenos resistentes a los medicamentos; y abogar por acciones concretas en respuesta a la RAM, basándose en la resolución de la Asamblea Mundial de la Salud, la Reunión de Alto Nivel de la Asamblea General de las Naciones Unidas sobre la RAM de 2024 y la cuarta Conferencia Ministerial Mundial de Alto Nivel sobre la RAM.



Sujeto irrumpe en fiesta y realiza disparos con arma de güero en la comunidad Tierra Nueva, una mujer presentó crisis nerviosa y fue trasladada al hospital IMSS-Bienestar
AGENCIAS
MARTÍNEZ DE LA TORRE
La celebración de una fiesta en la localidad de Tierra Nueva, perteneciente al municipio de Atzalan, terminó en momentos de tensión luego de que un individuo arribó al lugar y realizó detonaciones con un arma de fuego, para pos-

teriormente darse a la fuga. A pesar del susto entre los asistentes, no se reportaron personas heridas por impacto de bala. El hecho ocurrió alrededor de las 22:00 horas del domingo, cuando corporaciones de seguridad recibieron el reporte de que un sujeto había accionado una escopeta durante una fiesta en la zona, cercana a Loma de las Flores.

Inicialmente se informó que había dos personas lesionadas; sin embargo, más tarde se confirmó que no hubo heridos de gravedad. Únicamente una mujer presentó una fuerte crisis nerviosa, lo que le provocó una descompensación. Fue trasladada en un vehículo particular hacia el hospital IMSSBienestar de esta ciudad, donde quedó
internada para su valoración. La unidad fue escoltada por elementos policiacos, quienes la interceptaron en la colonia Altamirano.
Elementos de la Policía Municipal y de la SSP implementaron un operativo para localizar al presunto agresor; no obstante, hasta el cierre de esta nota no se había reportado ninguna detención.
Sujetos armados a bordo de un vehículo rojo lo atacaron a balazos, en Martínez de la Torre
REDACCIÓN
MARTÍNEZ DE LA TORRE
Un hombre identificado de manera extraoficial como Jesús Antonio G. M., alias “El Fresa”, fue asesinado a balazos la tarde de este lunes en la calle Manuel Mateos, entre prolongación Allende y Alfinio Flores, en la colonia Melchor Ocampo. La zona fue asegurada por corporaciones policiacas.
abrieron fuego en repetidas ocasiones, presuntamente entre nueve y diez disparos, para luego huir con rumbo hacia el Libramiento.
El hombre falleció de manera instantánea, por lo que ya nada pudo hacerse para brindarle auxilio.
ENRIQUE
COATZACOALCOS
Luego de estar convaleciente en un hospital, perdió la vida Mónica Delgado Andrade la elemento del IPAX que se accidentó en su motocicleta en el malecón a inicios de noviembre.
De acuerdo con los datos recabados, la dama murió el fin de semana y sus restos están siendo velados en una funeraria sobre la calle Román Marín casi esquina con Bravo del centro de la ciudad.
La policía auxiliar será trasladada al municipio de Agua Dulce de donde es originaria, ahí la sepultarán amigos, familiares y compañeros de IPAX.
El pasado 3 de noviembre, en el
malecón casi esquina con Abraham Zabludovsky se registró el percance donde Mónica manejaba su moto Vento color gris, fue impactada por un automóvil Jetta color negro, posteriormente se habría proyectado contra un taxi de la ciudad, quedando debajo del vehículo y siendo aplastada.
Al momento del hecho conductores se detuvieron para retirar el vehículo que estaba encima de Mónica.
Posteriormente fue auxiliada por personal de Alfa y Omega y elementos de emergencia, quienes la trasladaron a un hospital donde posteriormente perdió la vida.
Con su fallecimiento, se suman en total 11 personas muertas en accidentes en moto, el pasado viernes otro motociclista murió consecuencia de las lesiones. Muere mujer que
De acuerdo con los primeros reportes, alrededor de las 15:50 horas, la víctima fue interceptada por varios sujetos que viajaban en un vehículo color rojo. Los agresores descendieron de la unidad y

Al sitio arribaron elementos de la Policía Municipal y de la Secretaría de Seguridad Pública, quienes acordonaron el área y solicitaron la intervención de Policía Ministerial y Servicios Periciales para las diligencias correspondientes.
El cuerpo fue trasladado al Servicio de Medicina Forense, donde se le practicará la necropsia de ley.

AGENCIAS MISANTLA
Varios pasajeros se llevaron tremendo susto, al impactarse la camioneta en que viajaban contra un camión materialista, somo siempre sucede en estos casos, el trabajador del transporte público manejaba de forma imprudente y casi mata a todo su pasaje.
El accidente ocurrió la tarde de este domingo, sobre la carretera estatal Misantla - Martínez, justo a la altura de la curva “Del Zapote”, por dónde una camioneta Nissan del Transporte Mixto Rural al invadir el carril contrario colisionó contra un camión materialista.
Los pasajeros resultaron con heridas leves, solo crisis nerviosa y un pasajero fue trasladado al hospital para su valoración y atención médica.
Se esperaba la presencia de las autoridades de vialidad y preventivas para que tomaran conocimiento de este percance, dónde se registraron daños materiales cuantiosos.



Una mujer identificada como Reyna Esther M. R. fue localizada sin vida en una habitación del motel Siesta, en Las Choapas. Ingresó la noche previa con un hombre adulto y tres adolescentes que abandonaron el lugar por separado. Empleados del motel Siesta, ubicado en la colonia Aviación, encontraron el cuerpo alrededor de las 13:00 horas del domingo 16 de noviembre, cuando abrieron la habitación 6 para realizar limpieza. La mujer estaba sobre la cama, boca abajo y cubierta con una sábana.
Se incendia edificio
ENRIQUE BURGOS
COATZACOALCOS
Se registró un incendio en el interior del abandonado Hotel Margot Plus, en pleno Centro de Coatzacoalcos, lo anterior generó la movilización de elementos de Protección Civil, Bomberos y corporaciones policiacas.
El siniestro se presentó cerca de las 09:20 de la mañana en la esquina de Ignacio Zaragoza y José María Morelos.
Una llamada al número de emergencias 911 alertó sobre la presencia de humo que salía del inmueble.
Ante esto, autoridades policiacas y personal de Protección Civil y Bomberos acudieron al lugar y la zona fue acordonada para permitir las labores de los elementos, quienes ingresaron al edificio para sofocar las llamas.
Más tarde fue identificada como Reyna Esther Martínez Reyes, de 26 años, mesera en un restaurante ubicado en la autopista Las Choapas–Ocozocoautla, a la altura del kilómetro 29.
La familia informó que el sábado, a las 18:30 horas, dos hombres llegaron al domicilio de la víctima en la colonia El Arbolito con el argumento de llevarla a su trabajo. De acuerdo con las primeras indagatorias, esa misma noche Reyna Esther ingresó al motel junto con un hombre adulto y tres adolescentes. Horas después, los cuatro salieron por separado durante la madrugada del domingo

Jorge García Cruz comandante de bomberos, informó que como en otras ocasiones el incendio fue causado por personas en situación de calle que quemaban cobre en la planta baja.
“En la planta baja algunas personas intentaron quemar cobre y esto alarmó a los vecinos. Ingresamos y sofocamos el fuego; el incendio estaba en la parte final del elevador y el humo salió por la parte superior, lo que generó la alerta”, indicó.
Fueron varios minutos en los que se realizaron las tareas de sofocamiento, pues se temía que por el tipo de material se pudieran reactivar las llamas.
Hasta este lunes 17 de noviembre se desconoce la identidad del hombre y de los tres menores de edad. La Fiscalía General del Estado inició una carpeta de investigación para conocer la causa de muerte y establecer la posible participación de las personas que ingresaron con ella. Policías ministeriales revisan videograbaciones internas del motel para obtener detalles sobre los movimientos registrados esa noche. El 25 de noviembre se conmemora el Día Internacional para la Eliminación de la Violencia contra las Mujeres, en medio de un aumento de atenciones y denuncias en las instituciones estatales.

La vialidad fue cerrada, pero una vez concluyó la revisión del edificio, el cruce fue reabierto.
Los incendios en edificios abandonados es algo que se ha vuelto cada vez más común en Coatzacoalcos, desde hoteles abandonados, restaurantes y hasta viviendas que están inhabitadas, los siniestros son provocados por personas en situación de calle.
El abandonado Hotel Margon fue denunciado en agosto de este año por vecinos del centro de la ciudad, quienes señalaron que se ponía en riesgo la seguridad de los peatones y habitantes en general, por sus malas condiciones y uso de personas de la calle.

El Heraldo de Xalapa
El Heraldo de Tuxpan
Martes 18 de Noviembre de 2025 www.elheraldodetuxpan.com.mx
Martes 18 de Noviembre de 2025
@HeraldoXalapa
@Heraldo_Tuxpan

Sujetos armados a bordo de un vehículo rojo lo atacaron a balazos, en Martínez de la Torre. PASE A LA 21
Sujeto irrumpe en fiesta y realiza disparos con arma de fuego, en la comunidad Tierra Nueva. El agresor se dio a la fuga. PASE A LA 21

Conductor de Transporte Mixto Rural de Misantla choca contra camión volteo, al invadir carril contrario. PASE A LA 22

SE INCENDIA EDIFICIO
Ahora fue el extinto hotel Margot; en pleno centro de Coatzacoalcos, causando zozobra. PASE A LA 22
